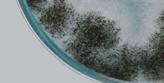
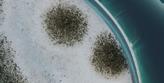

Aktuell — Seite 04
Gedanken zum Tag der Solidarität

Katholischer Verband der Werktätigen
Kommentar — Seite 19 Faires Südtirol
Sonderthema — Seite 32

Bauen, Energie, Sanieren

Aktuell — Seite 04
Gedanken zum Tag der Solidarität

Katholischer Verband der Werktätigen
Kommentar — Seite 19 Faires Südtirol
Sonderthema — Seite 32

Bauen, Energie, Sanieren
AKTION VERZICHT
Fastenzeit: „Sharing is caring“, das ist das Motto der diesjährigen „Aktion Verzicht“, die auch in ihrer 19. Ausgabe eine „Aktion unVERZICHTbar“ bleibt. Von Aschermittwoch, 22. Februar, bis Karsamstag, 8. April, wird die Bevölkerung dabei zum Mitmachen und Teilen aufgerufen, wobei sich das Teilen nicht nur auf materielle Güter bezieht. Auch Werte, Haltungen und Ideale können und sollen geteilt werden – mit einem eigenen Geschenkanhänger.
Witwentagung
Verwitwete und Alleinstehende treffen sich am Sonntag, 26. März um 09.30 Uhr in der Cusanus Akademie in Brixen zur traditionellen Tagung. Inge Patsch, Gründerin des Tiroler Instituts für Logotherapie und Existenzanalyse nach Viktor E. Frankl, hält ein Referat mit dem Titel „Ich zuversichte!“.
Seniorenmesse in Bruneck
Der Seniorengemeinderat und der KVW Bezirk Pustertal organisieren am 18. März ab 10.00 Uhr die Seniorenmesse im Michael Pacher Haus in Bruneck.
Steuerklärung
Die Steueraktion des KVW Service startet mit Ende März. Bitte über mycaf.eu oder unter der allgemeinen Nummer 0471 080 730 einen Termin vereinbaren.
Sorg di net, wos ondra Leit denkn. Sie tins net soffl oft.
Liebe Leserinnen, lieber Leser!
Verkehrte Welt: mehr Hilfesuchende, aber größerer finanzieller Druck. Unser Patronat KVW-ACLI durchlebt nun schon seit einigen Jahren diese paradoxe Situation. Staatliche und regionale Beiträge werden zu wenig angepasst. Dabei erfüllt das Patronat eine wichtige Funktion: es ist das Bindeglied zwischen Bürger:innen und öffentlichen Einrichtungen wie INPS, INAIL und Regionalund Landesämtern.
Das Patronat begleitet die Hilfesuchenden bei verschiedenen Anträgen im Bereich der Vor- und Fürsorge. Auch wenn einiges dank der Digitalisierung persönlich mittels digitale Identität beantragt werden kann, können dies längst nicht alle. Viele sind mit der „Zettelflut“ überfordert und brauchen dringend Unterstützung.
Damit die institutionellen Aufgaben des Patronats auch weiterhin flächendeckend angeboten werden können, ist dieses zusätzlich auf Spenden angewiesen. Die zugewiesenen Beiträge reichen bei weitem nicht aus, all die Dienstleistungen in verschiedensten Außenstellen auch weiterhin zu gewährleisten. Jedes Jahr am 3. Fastensonntag wird der diözesane Tag der Solidarität begangen. Dieses Jahr fällt er auf den 12. März. Die Kirchensammlung geht an diesem Sonntag an unser Patronat.
Leisten wir alle einen kleinen Beitrag, damit Solidarität erhalten bleibt!
Ihr Werner Atz

Kompass Monatszeitschrift der Südtiroler Werktätigen
Pfarrplatz 31
39100 Bozen
Tel. 0471 300 214
Fax 0471 982 867
pressereferat@kvw.org
www.kvw.org
facebook.com/kvw.verband
Im KVW Mitgliedsbeitrag enthalten ist das Abonnement von einem Euro für die Zeitschrift.
Herausgeber und Eigentümer: Katholischer Verband der Werktätigen VFG
Eintragung beim Landesgericht in Bozen unter 70/54 vom 19.06.1954
ROC: Nr. 5506
Verantwortliche Direktorin: Maria Lobis
Redaktion: Iris Pahl
Redaktionsteam: Werner Steiner, Karl Brunner, Maria Kußtatscher, Josef Bernhart, Herbert Schatzer, Leonhard Resch, Werner Atz
Erscheinungsweise: Jänner, März, Mai, Juli, September, November
Redaktionsschluss: am 1. jeden vohergehenden Monats
Auflage: 38.000
Grafik und Layout: mediamacs.design
Druck: LANAREPRO Ges.m.b.H.
Fotos: KVW Titelbild: unsplash

Mit diesem kleinen Wort begeht die Diözese Bozen Brixen am 3. Fastensonntag den Tag der Solidarität und stellt das Patronat KVW/ACLI in den Mittelpunkt der Aufmerksamkeit.
TEXT: CHARLY BRUNNERIn den letzten Jahrzehnten hören und lesen wir immer wieder, dass vor allem das Individuum wichtig ist, wie sehr die Selbstverwirklichung im Zentrum des Interesses stehen soll und dass die Befriedigung der individuellen Wünsche uns persönlich Erfüllung und der Gesellschaft Wohlstand bringt. „Kauf Dich glücklich und dann geht es allen gut!“ könnte dies zugespitzt zusammengefasst werden. Viele Menschen haben im Rahmen ihrer finanziellen Möglichkeiten diesen Weg auch beschritten, zumal die Jahrzehnte davor von Verzicht und einer Überbetonung der Gemeinschaft geprägt waren. Wer konnte es sich in den 50er-Jahren schon leisten, anders zu sein? Die Unterordnung in die Gemeinschaft war noch mehr als heute ein Muss. Wen wundert es, dass die neu gewonnene Freiheit auch gerne genutzt wurde.
Mittlerweile bekommt die Erfolgserzählung des großen „Ichs“ deutliche Brüche: Mit dem überbordenden Konsum kann unsere Erde – obwohl sie uns mehr als reich beschenkt – nicht mithalten. Die ökologische Krise steht also in einem direkten Zusammenhang damit. Auf der anderen Seite lässt sich durch einen Kaufrausch kein Glück erzwingen. Der ewige Kreislauf des Wünschens wird gerade nicht unterbrochen, wenn wir das Gewünschte bekommen. Wir wünschen munter weiter. Die Zufriedenheit hat sich auch nicht automatisch gesteigert. Das Maß an Unzufriedenheit ist angesichts der vielfältigen Möglichkeiten und der Fülle des Angebots ein deutliches Krisenzeichen, die Zunahme an psychischen Erkrankungen wohl ebenso.
Diese zugegeben vereinfachende Analyse der gesellschaftlichen Situation soll kein Plädoyer dafür sein, nicht auf eigene Bedürfnisse und damit auf sich zu achten. Schon das Doppelgebot des Neuen Testaments – „Du sollst deinen Nächsten lieben wie Dich selbst!“ (Mt 22,39) –verdeutlicht, dass es um eine Ausgewogenheit zwischen dem Ich und dem Wir, um ein „Sowohl-als-Auch“ geht.
Dabei kann uns das Danken eine wichtige alltägliche Erinnerung sein: Wenn wir danken, anerkennen wir, dass es andere in unserem Leben braucht und sagen der anderen Person gleichzeitig, dass wir das schätzen. Im Danken ver-
stehen wir, dass wir in ein Netz der Gemeinschaft hineinverwoben sind. Eigentlich ein schönes Bild! Wir stehen nicht isoliert im kalten Wind der Einsamkeit, sondern dürfen wieder neu entdecken, wie sehr wir alle zusammenhängen. Diese Erfahrung konnten wir auch in der Corona-Pandemie machen: Alle sitzen in einem Boot und der Zusammenhalt ist ein wichtiger Schlüssel zur Krisenbewältigung. Diese Erkenntnis ist von großem Wert für die anstehenden Transformation unserer Gesellschaft hinein in eine Phase, wo wir wieder mehr auf die Zusammenhänge blicken und uns nicht nur isoliert betrachten; Wo begriffen wird, dass sich das
eigene Verhalten auf die Umwelt, die Mitmenschen und aufgrund der weltweiten Produktionsprozesse sogar auf die Migrationsbewegung etc. auswirkt. Wir dürfen uns hineingewoben fühlen in eine Gemeinschaft und müssen nicht alles allein bewältigen, sehr wohl aber unseren je eigenen Beitrag leisten. An beides kann uns das Danke immer wie-

der neu erinnern und uns schließlich in einem weiteren Schritt dazu ermuntern, uns für das Gemeinwohl einzusetzen, weil wir verstanden haben, dass wir immer Teil einer Gemeinschaft sind, die uns trägt und in der wir mittragen.
Auch dafür: Danke!
Oft ist das, was man für das Richtige hält, gar nicht das wirklich Richtige
Primeln Im Topf Ø 10 cm
Dauertiefpreis 1.10
Universalrasen GARTENmarkt. Universell einsetzbare Mischung als Nutz- und Zierrasen, strapazierfähig und schnell keimend, 1 kg



12
Dauertiefpreis 8.50

Pflanzensubstrat Terrapreta. Langjähriger Bodenverbesserer, hochwertige Düngung, 100% aus Südtirol, 20 l
Hochbeet Gmünd. Aus Fichtenholz, mit Handlauf, inkl. Gewebefolie, 146 x 74 x 74 (H) cm


19.95
- 20% 24.95
127.95
- 15% 149.95
Die Corona-Pandemie scheint vorüber. Aber die sozialen Folgen bleiben. So das Resümee von Bezirkspräsident Dieter Pinggera bei seinem Treffen am 16. Januar 2023 mit dem Bezirksausschuss des KVW Vinschgau. Dieser hatte den Bezirkspräsidenten zu einer persönlichen Aussprache eingeladen, um mit ihm über sozial- und gesellschafpolitische Themen zu sprechen, Fragen zu stellen und darauf eine Stellungnahme von lokalpolitischer Seite zu erhalten.
Dieter Pinggera ging in seinen Ausführungen auf alle Bereiche des gesellschaftlichen Lebens ein. Auf die Gesundheitsversorgung ebenso wie die Sozialdienste, die von den Bezirksgemeinschaften im Land geführt werden, bis hin zu den Themen Verkehr, Wohnen und wirtschaftliche Entwicklung. Einen Schwerpunkt seiner Ausführungen bildete die aktuelle Situation am Krankenhaus Schlanders. Dort sei es, so der Bezirkspräsident, letzthin in Bezug auf die Verfügbarkeit von Ärztinnen und Ärzten besser geworden, jedoch bestünde derzeit ein großer Bedarf an zusätzlichen Pflegekräften. Diese fehlen allerorts. Der Südtiroler Sanitätsbetrieb sei seit Jahren intensiv bemüht, Pflegerinnen und Pfleger auch aus anderen Regionen und Ländern, sogar aus anderen Kontinenten anzuwerben. Die Aufgabe ist schwierig, aber nicht hoffnungslos. Jedenfalls, so Dieter Pinggera müsse laufend vor allem mit potenziellen Arbeitskräften, die aus Südtirol stammen, sich aber aktuell noch im Ausland befinden, kommuniziert und Kontakt gehalten werden. Denn viele kämen über kurz oder lang gerne in unser Land zurück. Der KVW Vinschgau ist hier ebenso bemüht, zu unterstützen, durch Information über Arbeitsmöglichkeiten und -bedingungen, aber auch durch die Suche nach Unterkünften vor Ort.

Ein weiteres Thema waren die Sozialdienste, die laut Dieter Pinggera die Krise relativ gut überstanden hätten, vor allem organisatorisch. Dennoch seien auch hier die Mitarbeiterinnen und Mitarbeiter müde und vor allem in der
Hauspflege die Situation schwierig, da Menschen daheim gepflegt werden, die eigentlich in einer stationären Einrichtung betreut werden müssten. Zu stärken seien im Sozialbereich vor allem niederschwellige Angebote. Schließlich kam der Bezirkspräsident auf das leistbare Wohnen zu sprechen, die Mobilität und die zunehmend aussterbenden Ortszentren. Die Baukosten seien enorm gestiegen und auch in der Peripherie der Wohnungsmarkt begrenzt. Hier könnte die nachhaltige Mobilität, sprich eine attraktive Zuganbindung in die Zentren helfen, aber vor allem die Verzögerungen bei der Tunnelsanierung auf der
Töll stehen diesem Ziel entgegen. Jedenfalls wird dort intensiv weitergearbeitet, um zumindest bis zum Schulbeginn im Herbst durchgängig fahren zu können. In den nächsten Jahrzehnten sind attraktive Bahnverbindungen bis hin zu einem 15-Minutentakt und mit einer starken Kapazitätserhöhung auf der Vinschger Bahnlinie bis nach Bozen geplant. Ein Ausblick, der Hoffnung macht, wenngleich die Zeitachse bei solchen Vorhaben erfahrungsgemäß mit einem großen Fragezeichen behaftet ist.
TEXT UND FOTO: JOSEF BERNHART

Sexueller Missbrauch an Kindern und Jugendlichen ist ein weitverbreitetes Verbrechen, über das kaum gesprochen wird. Es betrifft Schule, Kirche, Freizeit, Sport und die Familie. In dem 2022 bei Edition Raetia erschienenen Buch „Wir brechen das Schweigen“ von Veronika Oberbichler und Georg Lembergh haben Südtiroler Betroffene erstmals ihr eigenes Schweigen gebrochen: In einfühlsam geführten Gesprächen mit der Psychotherapeutin Veronika Oberbichler erzählen sie von ihren Erlebnissen, wie es zum Missbrauch kam und wie sie meist auf Unverständnis stießen, sobald sie sich jemanden anvertrauten. Aber sie berichten auch von ihrer Aufarbeitung und einem gelungenen Leben danach.
In Südtirol ist es immer noch ein Tabu, über sexuellen Missbrauch zu sprechen. Und zusätzlich ist das Wissen zum Thema (Was versteht man überhaupt unter sexuellem Missbrauch) sehr gering. Es herrscht zudem eine große Unbeholfenheit, mit dem Thema angemessen umzugehen: Wie als Angehöriger reagieren? Welche Anlaufstellen gibt es? Wie soll man vorgehen, um Betroffene zu unterstützen?
Der KVW organisiert auf Landesebene 6 Autorentreffen für unsere Ehrenamtlichen aus den Ortsgruppen, die das Thema dann in ihre Ortsgruppen tragen können und entscheiden, ob und wenn ja, wie sie es aufgreifen wollen. Moderiert werden die Abende von unserem geistlichen Assistenten Karl (Charly) Brunner, der zudem jeweils aus KVWPerspektive und aus Perspektive der Christlichen Soziallehre ins Thema einführen wird. Des Weiteren wird es an den Abenden ein Gespräch mit der Autorin und Leseabschnitte aus dem Buch geben; es können im Anschluss Fragen gestellt werden.
Am Vormittag des letzten Tages im alten Jahr ist der emeritierte Papst Benedikt XVI. gestorben und die Nachricht verbreitete sich schnell um die Welt. Schon in den Tagen davor ging die Medienmaschinerie los und die teils erneut ausgestrahlten oder aber für den Anlass bereits in der Schublade befindlichen Berichte flossen nach knappen Anpassungen üppig über den Äther. Dabei reichte die Bewertung von „erzkonservativem Bewahrer“ über den „paradeintellektuellen Kritiker der zeitgenössischen Kultur“ bis hin zum „kindlich frommen Beispielgläubigen“, verbunden mit dem Ruf: „Santo, subito!“ Dieser Versuch, einen Menschen auf ein Schlagwort zu reduzieren, liegt im Interesse der Medien, weil es letztlich unserem Bedürfnis nach einer einfachen Einordnung entspricht. Wird das der Person des Verstorbenen aber nur ansatzweise gerecht? Natürlich nicht!
Mich hätte es sehr interessiert, dem Menschen Joseph Ratzinger zu begegnen, von seinen Glaubens- und Lebenserfahrungen, seinen Zweifeln, Sorgen und Freuden zu erfahren und von ihm über sein Ringen, Versagen und das Geglückte in seinem Leben zu hören. Die Begegnung mit der konkreten Person, die so viel mehr ist, als ein Schlagwort mit einem Stempel der Einordnung, hätte mich gereizt.
Buchvorstellungen mit den Autoren gibt es demnächst in:
ɏ Meran OST WEST CLUB
9. März, 19.30 Uhr
ɏ Brixen Cusanus Akademie
17. März, 19.30 Uhr Reihe Cusanus Dialog
Diese Art von Berichten sind exemplarisch für unseren medialen Umgang mit Menschen, die in der Öffentlichkeit stehen. Machen wir uns bewusst, dass sie alle – seien sie gerade hoch im medialen Kurs oder werden sie gerade „medial ausgelöscht“, weil sie einen Fehler begangen haben – viel mehr sind, als die Schlagzeilen über sie!
Karl Brunner, geistlicher Assistent im KVWÜber die Fahrpläne und andere Themen rund um den öffentlichen Nahverkehr haben sich Landesrat Alfreider und die Vorsitzenden der Südtiroler Seniorenverbände kürzlich in Bozen ausgetauscht.
TEXT: LPA
Im Mittelpunkt des Gesprächs zwischen Mobilitätslandesrat Daniel Alfreider und den Vorsitzenden der Südtiroler Seniorenorganisationen Otto von Dellemann (Seniorenbund), Maria Kusstatscher (KVW) und Theresia Agreiter Larcher (Bauernbund) standen die gedruckten Fahrpläne für den öffentlichen Nahverkehr sowie die parallel laufende Weiterentwicklung des digitalen Angebotes. Landesrat Alfreider unterstrich dabei, dass der konstante Austausch mit den Sprechern der älteren Menschen in Südtirol zum öffentlichen Nahverkehr in Südtirol bedeutsam sei: „Wir wissen, wie wichtig die öffentliche Mobilität für unsere älteren Mitbürger und Mitbürgerinnen ist, da sie auch zur gesellschaftlichen Teilhabe beiträgt. Gerade diese Altersgruppe nimmt das umweltfreundliche Nahverkehrsangebot in Anspruch und verzichtet auf das Privatauto.“

Zusammen mit dem Südtiroler Seniorenbund, der Seniorenvereinigung im Südtiroler Bauernbund und dem Katholischen Verband der Werktätigen (KVW) wurde auch dieses Jahr die Zusammenarbeit für die Verteilung der gedruckten Bezirksfahrpläne fortgeführt.
Das Weiterbildungsprogramm soll weiterhin die Einführungskurse zur Südtirolmobil-App beinhalten und an die Bedürfnisse der älteren Menschen angepasst werden.
Maria Kusstatscher zeigte sich erfreut über die guten Verbindungen im öffentlichen Personen- Nahverkehr und für die günstigen Kosten der Senioren-JahresAbos. Die ältere Generation benutzt Bus und Bahn gerne im Alltag und für Aus-
flüge. Das Senioren-Abo hat sich bewährt. Die Anwendung bleibt mit der Umstellung auf die neuen Entwertungsgeräte gleich wie bisher: Die Karte zum Entwerten einfach an das Lesegerät halten.
Otto von Dellemann dankte dem Landesrat für den Druck der Fahrpläne, die für viele ältere Menschen wichtig sind.
Nicht alle können die Umstellungen auf die digitalen Angebote nützen.
Theresia Larcher begrüßte den Ausbau der Verbindungen bis in die peripheren Ortschaften. Das verhindert, dass die Bewohner dieser Orte vereinsamen oder gar ausgeschlossen werden.
Die Fahrplanbroschüren sowie auch die Sammelboxen sind seit Anfang Jänner 2023 wieder kostenlos erhältlich: am Bozner Busbahnhof, beim Infopoint Mobile in Brixen, beim Infopoint der SASA in Meran, Rennweg, beim Busbahnhof in Bruneck, bei den örtlichen Tourismusvereinen und in den Bezirksbüros des KVW und des Südtiroler Bauernbundes. Im Internet sind sie unter https://www.suedtirolmobil.info/de/meine-fahrt zu finden. Ebenso funktioniert die APP „Südtirolmobil“ auf dem Smartphone.
Zur Zeit werden die neuen Entwertungsgeräte in den Bussen installiert, die für Inhaber eines Südtirol-Pass-Abos nutzbar sind: die Karte zum Entwerten einfach an das Lesegerät halten.
Ein schlechtes Gedächtnis gibt es nicht, nur ein ungeübtes
Abschluss der KVW Bildung Ausbildung zum/zur Gedächtnistrainer:in

Südtirol erlebt auf dem Arbeitsmarkt eine eigenartige Situation. Wir erleben die Gleichzeitigkeit von Arbeitskräftemangel und niedrigen Gehältern in bestimmten Bereichen.
TEXT: WERNER ATZ





Schon seit Monaten klagt Südtirol über einen Arbeitskräftemangel selten gesehenen Ausmaßes.
Im Gesundheitswesen fehlt es schon seit Jahren an genügend Personal. Die Corona-Lockdowns haben viele Menschen aus der Gastwirtschaft in andere Branchen getrieben, wo sie jetzt oft bleiben. Wir tun uns schwer, Handwerker zu finden, uns fehlen Busfahrer und auch viele andere Branchen suchen händeringend nach guten Arbeitskräften.

Im Jänner haben in Masatsch in Kaltern 7 Teilnehmerinnen, nach erfolgreicher Prüfung, den Titel zur Gedächtnistrainer nach dem Curriculum vom Österreichischen Bundesverband für Lern-, Denk-, Gedächtnistraining und multimediales Aktivierungstraining, erworben.
Die Ausbildung wurde von der KVW Bildung in Zusammenarbeit mit der Ortsgruppe Kaltern und dem dortigen Bildungsausschuss organisiert und durchgeführt. Der Lehrgang umfasste 72 Weiterbildungsstunden, welche in Blöcken von Oktober bis Jänner stattgefunden haben. Frau Mag. Monika Puck, aus Salzburg, begleitete die Gruppe bravourös.

In der Ausbildung lernten die Teilnehmerinnen, wie man zu neuen Denkweisen motiviert werden kann. Es wurde auch gezeigt, was unser Hirn alles kann. Schon einfache Tipps und Tricks können eine große Wirkung auf die Gedächtnisleistung haben und diese Erkenntnis wird den Teilnehmenden sowohl in der Ausbildung als auch in den Gedächtnistrainings mitgeben. Die gemeinsam gelernten Techniken können auch im Alltag angewendet werden.
Andererseits kommen viele Arbeitnehmerinnen und Arbeitnehmer mit dem Gehalt immer weniger über die Runden. Die Inflation in einer Größenordnung von zehn Prozent und mehr verringert massiv die Kaufkraft der Südtirolerinnen und Südtiroler. Die Preise steigen, aber die Gehälter nicht. Lebensmittel, Treibstoff, Baumaterialien kosten gefühlt jeden Tag mehr. Wohnraum ist für immer weniger Menschen erschwinglich, und die Mieten sind hoch und höher.
Für viele Familien und Menschen wird es immer schwieriger mit dem Verdienten über die Runden zu kommen. Oft reichen in Familien zwei Gehälter nicht aus. Bis vor kurzem war „working poor“ (arm auch mit Erwerbsarbeit) ein Fremdwort in Südtirol. Jetzt müssen wir leider wahrnehmen, dass dieses Phänomen auch bei uns Einzug hält.
Eine Steigerung der Löhne ist wichtig und unumgänglich. Das Land muss das Geld für die öffentlich Bediensteten bereitstellen, und auch die Privatwirtschaft ist aufgerufen, die Gehälter anzupassen. Sie hat schließlich ein Interesse daran, dass ihre Mitarbeiter von ihrem Gehalt auch leben können.
Die 7 Teilnehmerinnen nach erfolgreicher Prüfung zur GedächtnistrainerinIn dieser Ausgabe stellt sich Vorstandsmitglied Herbert Schatzer vor und erklärt den Leser:innen in einem sehr persönlichen Beitrag seine Aufgaben beim größten Sozialverband Südtirols.
Nach den Landesausschusswahlen des KVW wurde im April 2021 der Vorstand neu gewählt. Folgende Bereiche wurden mir im Vorstand zugewiesen: KVW-Service GmbH, die Vertretung in der Verbraucherzentrale und im Arbeitsförderungsinstitut. Außerdem wurde ich auch in das Patronatskomitee entsandt.

Die KVW Service GmbH ist eine Dienstleistungsgesellschaft des KVW. Sie ist das größte Steuerbeistandszentrum und mit 10 Filialen in ganz Südtirol vertreten. Büros gibt es in allen KVW-Bezirken sowie in Neumarkt, Mals, Lana und Toblach. Das Bestreben ist es ganz nah am Bürger zu sein.
Mit der Tätigkeit der Service war ich vertraut, da ich früher hineinschnuppern durfte. Mit großer Freude setzte ich mich daran, wohlwissend, dass ich ein ausgezeichnetes Team mit zirka 50 Mitarbeitern rund um Dr. Christian Bosin übernehmen durfte.
Meine Aufgabe ist es die Service im Vorstand zu vertreten. Natürlich führe ich als Verantwortlicher Gespräche über interne Angelegenheiten mit dem Prokuristen Dr. Bosin oder nach außen mit KVW-Verantwortlichen sowie Vertretern der Politik. Ferner gehört es zu meiner Aufgabe bei Fragen zusammen mit dem Team Antworten zu finden, bzw. Entscheidungsprozesse zu beschleunigen.
Eine nicht ganz leichte Aufgabe, aber mit dem Team gelingt es. Mein Ziel ist es, unseren Mitgliedern und Kunden, den besten Kundendienst anzubieten.
Folgende Bereiche bewältigt das Service Team tagtäglich: die Erstellung der Steu-
ererklärungen (Mod. 730 und Redditi), die Ausführung der RED- ISEE und EEVE Erklärung, sowie die Abfassung des RWModells. Außerdem betreuen wir die Hausangestellten („badanti“), arbeiten Mietverträge aus und geben allgemeine Informationen und beraten in steuerlichen Angelegenheiten. Schwierigkeiten bereitet es, dass die Rahmenbedingungen auf Landes- bzw. auf Staatsebene öfters abgeändert werden.
Den KVW in der Verbraucherzentrale vertreten zu dürfen, ist für mich abwechslungsreich. Das Konsumverhalten der Menschen zu beobachten ist ein zentrales Anliegen unseres Verbandes.
Im Jahr 2022 und 2023 beschäftigt sich die Verbraucherzentrale hauptsächlich mit folgenden Sachbereichen:
1. Energieteuerung
Seit dem dritten Trimester 2021 haben die Preise für Strom und Gas eine starke Teuerung erfahren. Die Ausgaben für die Durchschnittsfamilie stiegen um über 90% (Tab. 1)
2. Aufgrund von Covid nicht genossene Leistungen
In der von der VZS angestrengten Pilot-Klage aufgrund von nicht genossenen Ski-Tickets konnte eine gütliche Einigung mit dem Anbieter erzielt werden. Die nicht genutzten Tage der Abos oder Tageskarten aus den Vorsaisonen können in den laufenden zwei Saisonen genutzt werden.
3. Dieselskandal: Musterfeststellungsklage in Braunschweig
Die Musterfeststellungsklage ging im Februar 2022 in die erste Verhandlungsrunde. Das Gericht verfügte eine Behandlung nach italienischem Recht; ein Gutachter muss innerhalb Juni 2023 die rechtlichen Fragen klären.
Kosten in Euro (Steuern inkl.) Vergleich
Kostenschätzungen der jeweiligen Trimester, jeweils für 12 Monate im Voraus
Ich möchte einen kurzen Blick auf die Herausforderung zum Schutz der Verbrauer 2023 werfen.
1. Inflation, Treibstoff, Darlehen Im laufenden Jahr reißt die Teuerungswelle nicht ab. Lebensmittel, Treibstoffe, Darlehensraten, vieles wird teurer. Die Verbraucherzentrale zeigt auf, wieviel Prozent eine Erhöhung sein könnte, und gibt Tipps, um unnötige Ausgaben zu vermeiden.
2. Neue EU-Vorgaben und Gesetze Aus verschiedenen Richtlinien kommen neue EU-Vorgaben (z.B. in Bezug auf die Preisangaben bei Schlussverkäufen), die im Laufe des Jahres in die nationalen Nor-men übernommen werden sollten. Unter anderem soll der Schutz der Verbraucher auf Verfassungsebene verankert werden.
3. Class Action gegen Finanzdienstleister Nexi
In Mailand steht die erste Verhandlung in der Class Action gegen Nexi an. Es geht darum, dass Nexi die Kreditkarten und dazugehörigen Daten der Nutzer nicht ausreichend schützt. Nexi zahlt bei Missbrauch keinen Schadensersatz.
Zusätzlich zur Service GmbH und zur Verbraucherzentrale vertrete ich den KVW auch im AFI. Beim Arbeitsförderungsinstitut steht der Lohnabhängige,
bzw. die arbeitenden Menschen im Mittelpunkt.
Im Jahr 2022 ging es für mich beim AFI vor allem um:
1. Öffentlicher Wohnbau
Der Arbeitstisch für den öffentlichen Wohnbau, dem ich angehöre, traf sich fünf Mal um den Landesgesetzentwurf zu durchleuchten. Entstanden ist ein elf Punkte umfassender Katalog. Leider wurde das Gesetz in aller Eile vom Landtag 2022 verabschie-det.
2. Soziale Mobilität in Südtirol
Es wurde eine Studie erstellt, welche die Frage beantworten sollte, wie schwer es in Südtirol ist, die soziale Leiter hochzuklettern. In anderen Ländern Europas ist dies leichter.
3. Arbeitsbedingungen in den Provinzen der Europaregion
Eine Studie über die Arbeitsbedingungen in der Europaregion wurde erstellt. Zum Beispiel ist bei belastenden Arbeiten ein klares NordSüd Gefälle feststellbar.
Der Ausblick für dieses Jahr ist nicht rosig. Die Pandemie, die Teuerungsrate, der Mangel an Fachkräften bereitet so manche Probleme. Die Schere zwischen arm und reich geht immer mehr auseinander. Ich werde mich in den unten angeführten Bereichen verstärkt einbringen
ɏ Mit großer Sorge blicke ich auf die kommenden Jahre, in Bezug auf die Lohnentwicklung. Das Leben wird teurer, die Löhne steigen nicht. Das lohnabhängige Einkommen genügt in vielen Fällen kaum zum Überleben.
ɏ Zudem werde ich im AFI den privaten und sozialen Wohnungsmarkt genau verfolgen. In Zusammenarbeit mit allen Gewerkschaften werde ich mich einbringen um nötige Reformen anzudenken.
ɏ Und nicht zuletzt ist mein Steckenpferd beim AFI der Wandel der Arbeitswelt. Die Veränderung der Arbeitswelt in den letzten Jahren und die Veränderung in den kommenden Jahren ist eine spannende Geschichte. Eine Studie soll in diesem Bereich im Herbst Antworten geben.
Meine KVW-Sendungen bei Radio Grüne Welle mit Mitarbeitern und ehrenamtliche Mitgliedern des Verbandes bereiten mir viel Freude.

Meine schönste Tätigkeit im KVW ist es aber nach wie vor nahe an den Mitgliedern zu sein. Ich besuche KVW-Jahresversammlungen, halte sehr gerne Vorträge im ganzen Land.
All diese Aufgaben bewältige ich mit Spannung und Freude. Ich bin begeistert, dass die Arbeit nicht ausgeht.

Ende Januar trafen sich die Frauen der KAB (Katholische Arbeitnehmer:innen Bewegung) Deutschland, Österreich der Schweiz und vom KVW Südtirol, (vertreten von Helga Mutschlechner) zur Vorbereitung für die 11. Sommerakademie 2024, welche in Österreich stattfinden wird. Vor Kurzem haben die Österreicherinnen das Ruder übernommen. Nach mehreren Vorschlägen, hat sich die Gruppe für das Thema: „Fair Sorgen in EU: Realität-Modelle-Perspektiven!“ für die nächste Sommerakademie entschieden. Thema wird die „Wertigkeit“ der Versorge- Arbeit in der Politik und Gesellschaft sein. Wer macht diesen 24 Stunden Job? Welche Arbeitsbedingungen müssen für ein menschenwürdiges Leben gegeben sein?
Bei dem Treffen wurde auch über die 10. Sommerakademie 2022, welche in Brixen stattfand, reflektiert. Sowohl der Inhalt als auch das Rahmenprogramm wurden sehr positiv bewertet. In den Gesprächen waren sich alle einig, dass neue Anreize geschaffen werden müssen, dass Frau und Mann wieder Lust haben sich in den Verbänden zu engagieren.
Nicht alle haben die gleichen Pläne für den Sonntag: einige wollen unbedingt raus in die Natur, andere machen es sich daheim gemütlich, einigen ist der Besuch des Gottesdienstes wichtig und wieder andere nutzen die Gelegenheit und engagieren sich in ihrer Freizeit für einen Verein oder üben ein Ehrenamt aus. So unterschiedlich wie der Sonntag für den Einzelnen ausschauen kann, so wenig ist er für die KVW Frauen verhandelbar. Seit Jahren schon setzen sie sich für den Schutz des Sonntags, vor allem des einkaufsfreien Sonntags, ein. Am 3. März wird der internationale Tag des freien Sonntags begangen.
In einer Welt in der vieles aus den Fugen gerät, ist Planbarkeit ein hohes Gut. Offene Läden am Sonntag verhindern aber, dass viele Familien einen gemeinsamen Tag verbringen können. Wer zum Beispiel im Handel arbeitet, ist oft auch am Sonntag zum Dienst eingeteilt. Darüber hinaus klagen viele Branchen über Personalmangel und die gestreckten Öffnungszeiten machen die Arbeit in den Geschäften nicht mehr attraktiv. Während große, internationale Ketten offen halten, tun
sich insbesondere auch lokale und periphere Einzelhändler schwer mitzuhalten.
„Bisher war der Sonntag ein Tag für eine gemeinsame Unternehmung. Dies soll auch bleiben“, so Heidrun Goller, Vorsitzende der KVW Frauen. „Zeit für sich, Zeit für die Familie, Zeit ohne Konsumzwang und Zeit für die Gemeinschaft ist uns lieb und teuer.“ Gleich dem Leitsatz folgend: „Sunnta frei. I bleib dobei!“ sensibilisieren wir KVW Frauen im Rahmen des internationalen Tags des freien Sonntags!
Es gibt selbstverständlich Arbeiten die auch an Sonntagen getan werden müssen: im Gesundheitswesen, in der Pflege, im öffentlichen Nahverkehr, in der Gastronomie und auch in der Landwirtschaft. Doch in anderen Bereichen ist eine Flexibilisierung der Arbeitszeiten nicht zwingend notwendig. Genau hier müssen Gesetzgeber und Wirtschaft lenkend eingreifen. Familienfreundliche Sonn- und Feiertagsruhe tun den eigenen Beschäftigten und der Gesellschaft als Ganzes gut.
Und auch der Konsument kann seinen Teil dazu beitragen: wird am Sonntag bewusst nicht eingekauft, wird es sich auf lange Sicht für die Wirtschaftstreibenden nicht mehr lohnen die Geschäfte offen zu halten.
Der Sonntag soll auch in Zukunft nicht verkaufsoffen sein, damit er wirklich ein besonderer Tag bleibt. Familienzeit ist unbezahlbar und die beste Investition für unsere Zukunft.
Die KVW Frauen werden am 3. März ein Lesezeichen als Symbol für die Wichtigkeit eines stressfreien, ruhigen Sonntags in allen Bezirken Südtirols verteilen.
Vieles bewegt uns Frauen: Gedankenfülle im Kopf, zu viel Arbeit, Gefühl der Überforderung und des FunktionierenMüssens, Ängste und Sorgen, zunehmende Belastungen, …
Was brauchst du? Was tut dir gut?
Gesellschaftlich, politisch und kirchlich sind wir in den letzten Jahren in Frauenfragen wenig weitergekommen. Dienste und Leistungen wurden sogar gestrichen, die Situation von Frauen hat sich insgesamt verschlechtert, ...
Vieles bewegt uns Frauen: Gedankenfülle im Kopf, zu viel Arbeit, Gefühl der Überforderung und des FunktionierenMüssens, Ängste und Sorgen, zunehmende Belastungen, …
Was brauchst du? Was tut dir gut?
Sechs Südtiroler Organisationen geben zwölf Impulse einer positiven Lebensgestaltung und laden ein, auf die inneren Stärken zu schauen, die Kraft geben für ein selbstbestimmtes, erfülltes und glückliches Leben.
WIE KANN ES GELINGEN, UNSERE ZUKUNFT GUT ZU GESTALTEN?
Wir wollen frauen.leben.stärken!
Gesellschaftlich, politisch und kirchlich sind wir in den letzten Jahren in Frauenfragen wenig weitergekommen. Dienste und Leistungen wurden sogar gestrichen, die Situation von Frauen hat sich insgesamt verschlechtert, ...
Wie kann es gelingen, unsere Zukunft gut zu gestalten?
Eine Aktion von:
ɏ Frauen im KVW
ɏ Katholischer Familienverband Südtirol (KFS)
Sechs Südtiroler Organisationen geben für die nächsten zwölf Wochen positive Impulse.
ɏ Katholische Frauenbewegung (kfb)
ɏ Landesbeirat für Chancengleichheit
Sechs Südtiroler Organisationen geben zwölf Impulse einer positiven Lebensgestaltung und laden ein, auf die inneren Stärken zu schauen, die Kraft geben für ein selbstbestimmtes, erfülltes und glückliches Leben.
ɏ Südtiroler Bäuerinnenorganisation (SBO)
ɏ Südtiroler Jugendring
Spenden für den KVW Hilfsfonds
ɏ KVW Ortsgruppe Kurtatsch, Reingewinn des Nudelsonntags
ɏ KVW Ortsgruppe Seis
ɏ KVW Ortsgruppe Laas
ɏ KVW Ortsgruppe Brixen
ɏ Maximilian Tötsch, Wiesen Pfitsch
ɏ Flora Rainer, Wiesen Pfitsch
ɏ Josef Guadagnini, Kurtatsch
Gesamtsumme 3.350 Euro
Bankdaten KVW Hilfsfonds
Raiffeisen Landesbank, IBAN: IT 61 Z 03493 11600 000300101788
ɏ Robert Tscholl, Eyrs
ɏ Annemarie Lang Schenk, Seis
ɏ Johann Ratschiller, Vetzan
ɏ Luis Torggler, Villanders
ɏ Monica Wolkan, Meran, Gedächtnisspende
ɏ Anonyme Spende
Noch nie hatte in der Gemeinde Natz-Schabs eine Wohnbaugenossenschaft um einen Baugrund angesucht, bis zu dem Moment, als sich die 4 Bauherrn und Bauherrinnen der Wohnbaugenossenschaft Weinberg zusammengetan und es versucht haben. 2017 war das.
So wie in vielen anderen Gemeinden, ist es auch in Natz-Schabs so, dass Baugrund rar und teuer ist. „Ich habe von der Möglichkeit gehört, eine Wohnbaugenossenschaft zu gründen, dass es als Gruppe leichter ist, einen Grund zugesprochen zu bekommen, dass man damit einheitlicher und auch günstiger bauen kann“, sagt der Obmann der Wohnbaugenossenschaft Weinberg Raas Wolfgang Bampi. „Um eine Genossenschaft zu gründen, braucht es mindestens 3 Bauherrn und so habe ich mich auf die Suche gemacht, diejenigen angesprochen, von denen ich wusste, dass sie bauen wollen“. Und das ist geglückt. „Zu viert haben wir dann als Wohnbaugenossenschaft Weinberg Raas bei der Gemeinde angesucht und unter Architekt Andreas Vallazza bald schon mit der Planung begonnen.“ Zwei Reihenhäuser und zwei Etagenwohnungen sollten realisiert werden. Alle Bauherren und Bauherrinnen
kommen aus Raas und als die Wohnbaugenossenschaft 2020 die Baukonzession ausgestellt bekam, ist schon ein erster großer Wunsch in Erfüllung gegangen. „Wir hatten auch viel Glück“, sagt der Obmann, „wir sind gut durch die Krisenjahre gekommen. Es gab kaum einen größeren Baustopp, auch nicht während Corona. Die Erhöhung der Materialkosten haben wir aufgrund frühzeitig abgeschlossener Verträge nicht zu spüren bekommen. Die beschäftigten Handwerker kamen alle aus der Umgebung.“
Inzwischen wohnen die Bauherren und Bauherrinnen schon seit gut einem Jahr in ihrem neuen Zuhause.
„Es gibt viele Vorteile, wenn man mit einer Genossenschaft baut“, sagt Obmann Wolfgang Bampi. „Man kommt leichter zu einem Baugrund, man baut einheitlich, man beauftragt gemeinsam Firmen
und kann damit bessere Preise aushandeln, viel gemeinschaftlich ausschreiben.“ Als Nachteil nennt der Obmann die viele Bürokratie und auch die vielen Sitzungen, die nötig sind um als Gemeinschaft eine Entscheidung im Sinne aller treffen zu können. „Aber das hat uns auch als Nachbarn nähergebracht, wir kommen bis heute gut aus und verstehen uns gut“. Das ist dem Obmann sehr wichtig und er wünscht sich, dass dies auch weiterhin so bleibt.
„Danken möchten wir der Gemeindeverwaltung Natz-Schabs, dem Bürgermeister Alexander Überbacher und besonders auch den beiden Projektleiterinnen Verena Prantner und Lisa Ploner von der Arche im KVW, die unsere Genossenschaft von Anfang bis Ende gut betreut und beraten haben.“
 TEXT: MONIKA GOGL
TEXT: MONIKA GOGL
Langstreckentransporte sind ein wichtiger Bereich im Weißen Kreuz, für den der Landesrettungsverein neue Freiwillige sucht. Die Malserin Ingrid Andreaus erzählt über diesen Dienst und rührt dabei auch kräftig die Werbetrommel.

Warum hast du dich für den Langstreckendienst entschieden?
Als langjährige Freiwillige der Sektion Mals hatte sich einmal die Gelegenheit ergeben, bei einem Langstreckentransport mitzufahren. Da ich Gefallen daran gefunden habe, war ich dann öfters bei einem Langstreckentransport mit dabei. Und seit meiner Pensionierung ist diese Tätigkeit im Weißen Kreuz eine wirklich großartige Lebensaufgabe für mich geworden.
Welche Voraussetzungen brauchtest du dafür? Welche Voraussetzungen sollte in deinen Augen jemand zum Langstreckendienst mitbringen?
Da ich, wie gesagt, schon bald ein Vierteljahrhundert diesem Verein angehöre, hatte ich alle Voraussetzungen für den Langstreckentransport. Ein Neueinsteiger sollte gerne reisen sowie flexibel, hilfsbereit und diskret sein. Auch ein
netter Umgang mit Patienten ist nötig. Und man muss in diesem Bereich natürlich auch Verantwortung übernehmen – für das Fahrzeug und seine Insassen.
Wo führen dich deine Fahrten hin?
Meine Fahrten führten mich von Süditalien samt Inseln bis hinauf in den Norden – Schweiz, Frankreich, Holland und Belgien miteinbegriffen.
Was gefällt dir besonders am Langstreckendienst?
Mir gefällt das Reisen. Bereichernd für mich sind aber auch die Kontakte zu verschiedenen Menschen anderer Länder sowie wertvolle Einblicke in andere Rettungsorganisationen und Gesundheitseinrichtungen. Zudem lerne ich auch die Kulinarik der verschiedenen Nationen kennen. Es gibt bei den Langstrecken-
transporten auch keine Stresssituationen wie sie beispielsweise im Rettungsdienst vorkommen können. Und zudem kann ich meinen geographischen und kulturellen Horizont immer wieder neu erweitern.

Würdest es weiterempfehlen?
Ja, natürlich. Ich würde einem jeden Rentner diesen Dienst weiterempfehlen. Man sieht und spürt, dass man gebraucht wird. Zudem hält diese Tätigkeit gesund und fit.
Was gibt dir dieser Dienst?
Eine kleine Spesenvergütung, Zufriedenheit, Dankbarkeit und viele neue Bekanntschaften.
Das Weiße Kreuz sucht Freiwillige für den Langstreckendienst, für den es auch eine Spesenvergütung gibt. Infos auf www.weisseskreuz.bz.it.
In der letzten Ausgabe des Kompass haben wir die EBCA, die europäische Bewegung der christlichen Arbeitenehmer:innen genauer kennengelernt und nun werden wir fortlaufend die einzelnen Mitgliedsorganisationen vorstellen. Der Reigen wird durch die KAB Schweiz Christliche Sozialbewegung in der Schweiz eröffnet, kurz KAB Schweiz.
Die Südtiroler schielen gerne zu ihren Nachbarn und so tun sie dies auch in die angrenzende Schweiz. Seit der Gründung des Katholischen Arbeitervereins St. Gallen im fernen Jahr 1899, aus dem die heutige KAB entstanden ist, ist die Aufgabe die materielle und geistige Besserstellung der Arbeiter:innen. Im Vergleich mit vielen andern Ländern hat die Schweiz ein gut ausgebautes Sozialsystem; dennoch gibt es auch hier einiges zu tun. Viele Menschen haben Schwierigkeiten mit ihrem Einkommen über die Runden zu kommen, Einwanderern aus fremden Kulturen wird mit Ablehnung begegnet, der Einfluss der katholischen Kirche schwindet. Die KAB und katholische Soziallehre will den Bürger:innen Orientierung bieten, die Gesellschaft mitgestalten und sich für eine lebendige Kirche einsetzen. Leitmotiv der KAB Schweiz ist „SehenUrteilen-Handeln“. Hervorstechend sind dabei auch das Hilfswerk Brücke Le Pont und das Institut für christliche Sozialethik, Trägerverein von ethik22.
Wir haben mit Armin Huerner, den KAB –Schweiz Vertreter in der EBCA gesprochen.

Kompass: Gemeinsam mit unserem geistlichen Assistenten Charly Brunner sitzen Sie im Leitungsgremium der EBCA. Wir kommt KAB Schweiz, bekanntermaßen kein EU Mitglieder, sich dazu in der europäischen Arbeitnehmerbewegung zu engagieren?
Die KAB Schweiz schaute schon immer gern über den Tellerrand hinaus. So kam es, dass die KAB Schweiz vorerst nur Mitglied der
EBCA war. Auslöser zur engeren Zusammenarbeit war dann das sog. Bodenseetreffen. Seit ca. 60 Jahren treffen sich KAB-Vertreter der an den Bodensee angrenzenden Bistümer einmal jährlich zu einem Austausch. Es sind dies St. Gallen, Basel (der an den Bodensee angrenzende Kanton Thurgau gehört zum Bistum Basel), Vorarlberg, Freiburg, Augsburg und Rottenburg-Stuttgart. Über diesen Kontakt kam die Anfrage aus Freiburg, ob ich an einer Mitarbeit in der EBCA interessiert sei.
Kompass: Genau wie Südtirol ist auch die Schweiz mehrsprachig. Ist die KAB Schweiz Ansprechpartner für alle Sprachgruppen? Wie schaut das in der Praxis aus?
Jede Sprachregion hat eine eigene Organisation mit wenig Kontakt untereinander: deutsche Schweiz: KAB Schweiz, französische Schweiz: CTC (Communauté de Travailleurs Chrétiens) – Kanyamibwa Melchior, Vorstandsmitglied CTC ist Koordinator der EBCA und schliesslich noch die italienische Schweiz: ACLI, Niederlassung der italienischen ACLI.
Kompass: Können Sie unseren Lesern jeweils ein herausragendes, aktuelles Projekt der beiden Initiativen BrückeLe Pont und Ethik22 nennen und ein wenig darüber berichten?
Weltweit leben heute mehr als 700 Millionen in extremer Armut. Die Brücke Le Pont setzt sich in über 30 Projekten in Afrika und Lateinamerika ein. Die Arbeitsweise fußt auf folgende Grundsätze für eine nachhaltige Veränderung der Bedingungen vor Ort: Förderung der beruflichen Kompetenzen, Einhaltung der Ar-
beits- und Menschenrechte und existenzsicherndes Einkommen. Beispielhaft dafür ist das Projekt Karité: 3600 Frauen aus dem armen Norden Benins stellen Sheabutter her. Sie lernen in Schulungen Techniken um die Nüsse des Karitébaums effizienter, umweltschonender und hygienischer zu Butter zu verarbeiten. Das Projekt hilft ihnen auch sich in Kooperativen zusammenzuschließen. So können sie sich gemeinsam weiterbilden, neue Käufer:innen ansprechen und bessere Preise für ihre Produkte aushandeln.
Die Projektteilnehmerinnen konnten ihr Einkommen im ersten Projektjahr durch die verbesserte Qualität des Produkts bereits um 20 Prozent steigern. Damit leisten sie einen wichtigen Beitrag zum kargen Einkommen ihrer Familien. Viele der Frauen berichten außerdem, dass sie durch das Projekt selbstbewusster geworden sind und ihre Arbeit in ihren Gemeinden stärker anerkannt wird.
Das Institut für Sozialethik, ethik 22, organisiert christlich fundierte Impulsveranstaltungen (z.B. Sozialtag) und räumt drängenden gesellschaftlichen Fragen breiten Raum ein und macht sie sichtbar. Ethik22 ist auf vielen Kanälen vertreten: Bei „radioEinfluss“ (www.ethik22. ch/einfluss) wird regelmäßig zu aktuellen Fragen diskutiert. Solche greift auch das gedruckte Magazin auf. Mit dem Newsletter erhalten viele Interessierte u.a. jeweils vertiefte Informationen zu den Themen der Volksabstimmungen in der Schweiz. Ethik22 hilft, die richtigen Fragen zu stellen, wenn aus sozialethischer Sicht ein Ja oder Nein zu Fragen zum Tierschutz, zum Klimawandel oder zur Ehe für alle oder auch zum Asylrecht auf der politischen Agenda stehen.
Genaue Zahlen dazu gibt es nicht, aber besonders in Südtirols Landeshauptstadt gibt es mehr als 130 Personen, die Abend für Abend keinen angemessenen Wohnraum haben und sich irgendwo einen Platz für die Nacht suchen müssen. Landesweit wird die Zahl auf 1.500 geschätzt, Tendenz steigend. Obdachlos und wohnungslos sind aber nicht gleichzusetzen: viele Menschen kommen eine Zeit lang bei Bekannten und Freunden und in Strukturen unter.
Ebenso vielfältig wie der Werdegang der Menschen, ist auch die Ursache, wieso sie kein Dach über dem Kopf haben und meist sind es auch mehrere Gründe. Häufig findet man bei Menschen, die auf der Straße leben müssen, strukturelle, individuelle oder systematische Gründe. Arbeitslosigkeit, geringe Einkommen, teure Wohnungen und Lebenshaltungskosten, können eine Wohnungslosigkeit ebenso verursachen, wie eine Trennung, familiäre Probleme oder der Tod einer nahestehenden Person. Besonders viele Betroffene können auch soziale Hilfen nicht in Anspruch nehmen, weil ihnen ohne Identitätsausweis oder Aufenthaltsgenehmigung die Berechtigung fehlt sich an öffentliche Institutionen zu wenden. Auch die mengelnde Sprachkenntnisse lassen Menschen, die sich auf der Flucht befinden, schneller in die Obdachlosigkeit abrutschen.
Dies hat dann auch zur Folge, dass diese Menschen nicht am gesellschaftlichen Leben teilnehmen können und körperliche und seelische Krankheiten chronisch werden. Ohne Adresse gibt es auch keine Aussicht auf Arbeit und die Möglichkeit wieder Anschluss zu finden, um sein Leben selbst in die Hand zu nehmen und ein „normales“ Leben zu leben. Die meisten Obdachlosen, auch in Südtirol, sind Männer, die aufgrund einer Notlage in eine schwierige Situation geraten.
Kurzfristige Hilfe ist nötig, aber langfristig soll Hilfe mehr sein als Nahrung, Kleidung oder auch ein Bett für eine Nacht sein. Diesen Ansatz verfolgen mehrere Projekte, so wie zum Beispiel das dormizil in Bozen. Es ist ein Nachtquartier für 25 obdachlos Frauen und Männer im Zentrum von Bozen, dass von Freiwilli-
gen getragen wird. Neun Privatpersonen haben 2020 den Verein housing first bozen EO gegründet und das domizil aufgesperrt. Ab Mitte 2023 wird das dormizil umgebaut und zum langfristigen Stützpunkt für obdachlose Menschen. Neun Personen ohne Dach über dem Kopf erhalten eine kleine Wohnung. Im Dachgeschoss können bis zu fünf weitere wohnungslose Menschen in einer vorübergehenden Notunterkunft schlafen.

Die Vinzenzgemeinschaft hat in der Bozner Kapuzinergasse vor kurzem ein Hygienezentrum eröffnet, wo Menschen eine Waschgelegenheit haben. Über Nacht ist es geschlossen.
Auch in Meran möchte man mit dem sog. Chancenhaus neue Wege gehen. Die Gemeinde Meran möchte obdachlosen Menschen in Zukunft eine begleitete Unterkunftsmöglichkeit anbieten. Damit nicht pünktlich mit Einbruch des Winters der Aufschrei wieder groß ist, braucht es langfristige Konzepte und Projekte. Die Politik ist gefragt, aber auch die Gesellschaft als Ganzes ist gefordert.
Das Konzept Housing first verfolgt den Ansatz Menschen unmittelbar eine eigene Wohnung anzubieten - mit Mietvertrag und ohne Vorbedingungen. Dieses „zu Hause“ soll den Menschen Kraft geben, all ihre anderen Probleme aktiv anzugehen. In Finnland hat man damit erstaunliche Erfolge erzielt: während im Rest Europas die Kurve der Obdachlosen steil nach oben steigt, ist die Zahl in Finnland rückläufig. Trotz der hohen Anfangsinvestitionen, Wohnungen anmieten und bauen, statt Notunterkünfte, sind die Kosten langfristig geringer, da der Sozialstaat durch resozialisierte Bewohner weniger belastet wird. Die Versorgung von Obdachlosen, bzw. Migranten auf der Durchreise, wird uns auch weiterhin beschäftigen. Nicht gedient ist den Menschen, die schon am Rand der Gesellschaft stehen, wenn weiterhin auf hektische Notlösungen für die kalten Wintermonate gesetzt wird, anstatt langfristige Lösungen zu suchen auch den Ausgegrenzten eine Chance zu geben. Um Menschen von der Straße zu holen, muss genügend Wohnraum zur Verfügung gestellt werden.
TEXT: IRIS PAHLMan kennt es auf den Nachrichten: Menschen stehen Schlange und werden von Freiwilligen mit gespendeten Lebensmitteln versorgt. Ganz so ist es in Mals nicht, aber auch im Vinschger Oberland gibt es eine Tafel, die bedürftige Menschen aus den umliegenden Ortschaften einmal wöchentlich mit Essen versorgt. Nun wird die Tafel ein Jahr alt und die Einrichtung hat sich bewährt und wird dankbar angenommen. Die Tafel in Mals ist die jüngste, der derzeit 10 Tafeln die, die Vinzenzgemeinschaft betreibt.

Einmal die Woche, immer donnerstags, sperren freiwillige Helfer die Türen des von der Gemeinde zur Verfügung gestellten Raums auf und erwarten dort ihre Kunden. Diese müssen bedürftig sein um überhaupt Zugang zur Tafel zu bekommen. Erst dann dürfen, die in Kartone und Taschen gepackten Lebensmittel, mitgenommen werden. „ Wir kennen die Familien, die zur Tafel kommen und es werden entsprechend der Anzahl der Famililemitglieder Pakete zusammengesetzt“, so Gertrud Telser Schwabl. Sie ist ehemalige Sozialreferentin der Gemeinde Mals, in verschiedensten Gremien des KVW aktives Mitglied (Vorsitzende KVW Frauen Vinschgau, Bezirksausschuss und Landesausschuss) und nicht zuletzt die Frau der ersten Stunde bei der Tafel in Mals. Sie bringt sich aktiv bei der Planung und Ausgabe von Lebensmitteln ein.
Vor der Gründung der Tafel wurden die Menschen, die die Tafel besuchen, alle von der Tafel in Prad mitversorgt. Damit die Menschen die Tafel leichter mit den öffentlichen Verkehrsmitteln erreichen können, aber auch aus Platzgründen und gestiegenem Bedarf, wurde schließlich die Tafel in Mals eingerichtet. „Dafür braucht es die Hilfe und Unterstützung vieler: die Gemeinde Mals hat einen Raum zur Verfügung gestellt, die Freiwillige Feuerwehr vor Ort hat die Aufgabe übernommen einmal im Monat beim Banco Alimentare haltbare Lebensmitteln wie Nudeln, Reis, Mehl, Thunfisch… von Bozen nach Mals zu bringen“, so Vizebürgermeisterin Marion Januth. Mittlerweile kann man in Mals auf ein 16 köpfiges Freiwilligenteam zählen, das die Lebensmittel auspackt und gerecht ver-
teilt. Auch die Dorfbevölkerung hilft mit und steuert Lebensmittel und Hygieneartikel bei, die in den Geschäften vor Ort in bereitgestellte Körbe gelegt werden können. Jede Woche liefert der Bäcker einen Sack Brot, die lokale Obstgenossenschaft stellt regelmäßig Äpfel zur Verfügung. Lebensmittel, die nicht mehr verkäuflich sind, da sie kurz vor dem Verfallsdatum stehen, werden von den Geschäften gespendet. „Außerdem werden wir auch immer wieder von der Großzügigkeit von Spender:innen überrascht. Gestern hat ein Mann frische Eier vorbeigebracht und so konnten wir unseren mehr als 30 Familien einige mitgeben“, freut sich Gertrud Telser Schwabl. Auch an die Freiwilligen sei schon gedachtt worden: eine Frau habe für alle Mitarbeiter der Tafel zu Weihnachten eine kleine Überraschung vor-
beigebracht. Viele der Menschen sind Stammkunden, einige brauchen aber auch oft nur kurzfristig eine Überbrückung wegen Verdienstausfall bei Corona beispielsweise oder krankheitsbedingt. Das Angebot wird vor allem von kinderreichen Familien, Menschen mit Migrationshintergrund und prekär Beschäftigten in Anspruch genommen. Ein Drittel davon sind Einheimische. Die Tafel in Mals wird gebraucht: damit die Menschen, die sonst schon oft am Rande der Gesellschaft stehen und nicht immer selbst Schuld daran sind, Unterstützung erfahren.
Neben dem Essen, spendet die Tafel und alle die sich dafür engagieren auch ein kleines Stück Würde und Erleichterung im oft herausfordernden Alltag.
TEXT: IRIS PAHLDie Soziale Mobilität betrifft uns alle. Dabei geht es aber nicht etwa um den öffentlichen Nahverkehr, sondern um die soziale Herkunft der Personen und um faire Chancen für alle bei Bildung, Beruf und Einkommen.
TEXT: ALESSANDRO FRANCISI / AFI ARBEITSFÖRDERUNGSINSTITUTDas Forschungsgebiet Soziale Mobilität erlange vor allem im Laufe des letzten Jahrhunderts besondere Aufmerksamkeit. Im Prinzip geht es dabei um eines: Chancengleichheit. Studien zur Soziale Mobilität erlauben, Veränderungen einer gesellschaftlichen Struktur und Bewegungen innerhalb dieser zu erkennen und somit Maßnahmen zu identifizieren, welche zu mehr oder weniger egalitären Gesellschaften führen.
In Südtirol war dieses Thema bislang unerforscht. Unser Alpenland zählt rund eine halbe Million Einwohner, welche im letzten Jahrhundert durch viele Ereignisse stark geprägt wurden, wie das Zusammenfließen mit mehreren Kulturen und eine starke wirtschaftliche Entwicklung, die heute aus Südtirol eines der wohlhabendsten Länder Europas macht.
Doch inwiefern ist es den Südtirolern möglich, die eigene soziale Position, unabhängig von ihrer sozialen Herkunft, zu verbessern? Antwort darauf bietet die Studie ‚Soziale Mobilität in Südtirol‘, welche vom AFI | Arbeitsförderungsinstitut zusammen mit dem Center for Advanced Studies der Eurac Research vorgestellt wurde.
Südtirol spiegelt italienische und europäische Tendenzen in Sachen Bildung, Beruf und Einkommen wider. Während einige Familien ihr Leben und ihre Tätigkeiten sorgenlos führen können, leben andere in Armut oder mit nur beschränken Möglichkeiten, ihre Position zu verbessern. Chancengleichheit impliziert, dass auch Personen, die aus einem benachteiligten familiären Umfeld stammen, im Laufe einer Generation durch Fleiß und persönlichem Verdienst in die höheren sozialen Schichten aufsteigen können – diese sind stark durch einen ho-
hen Bildungsgrad, einen angesehenen Beruf, oder ein hohes Einkommen geprägt.
Jedoch ist, zum Beispiel, obgleich die Möglichkeit auf Bildung in den letzten Jahrzehnten immer ausgeprägter wurde, die Chance, einen hohen Bildungsgrad zu erreichen größer, wenn mindestens ein Elternteil einen Hochschulabschluss besitzt. Auch die Chance, in der Berufsklasse der Eltern zu bleiben, ist sehr viel höher als die Chance, in einer anderen Berufsklasse zu landen.
Im Lande ist es knapp einem Drittel der Südtirolern gelungen, ihre Stellung im Vergleich zu der ihrer Eltern zu verbessern. Andererseits stürzen auch knapp einer von fünf im Vergleich zu den Eltern sozioökonomisch ab. Vieles dieser Veränderungsprozesse beruht auf etwa Veränderungen in der Beschäftigungsstruktur, im Lebensstandard oder im Bildungswesen. Andererseits erkennt man in Südtirol auch eine „Erbschaft“ des sozialen Status der Familie. Zwar ist dies aus der Perspektive derjenigen, die aus Familien mit höheren Berufsklassen stammen, durchaus positiv, da sie dann selbst sehr gute Chancen haben, selbst
hohe Positionen zu erlangen. Gleichzeitig bedeutet dies für Personen mit Eltern aus den unteren Berufskategorien beschränktere Möglichkeiten, die „soziale Leiter“ hochzuklettern. In der Literatur spricht man von „klebriger Decke“ bzw. „klebrigem Boden“.
Südtirol bietet durchaus gesellschaftliche Aufstiegsmöglichkeiten, obgleich diese nicht immer leicht erreichbar sind, und dies oftmals nur im beschränken Ausmaß. In der öffentlichen Debatte herrscht weitgehend Konsens über die Notwendigkeit, in die Chancengleichheit zu investieren. So ist es zum Beispiel entscheidend, den Zugang zu frühkindlicher Erziehung zu fördern oder Familien bei Schicksalsschlägen und Schockereignissen mit gezielten Stützprogrammen zu begleiten. Eine sozial mobilere Gesellschaft impliziert, dass die gesellschaftliche Stellung weniger von vererbten Privilegien und mehr von eigenen Fähigkeiten und Bemühungen bestimmt ist.
Die Studie ‚Soziale Mobilität in Südtirol' wurde im Rahmen einer Tagung vom AFI | Arbeitsförderungsinstitut zusammen mit dem Center for Advanced Studies der Eurac Research letzten Dezember nach fast zweijähriger Vorlaufzeit der Öffentlichkeit vorgestellt.

Für die Studie wurden 1.500 Personen telefonisch interviewt. Die Stichprobe ist für Südtirol repräsentativ.
Die Tagung wurde vollinhaltlich aufgezeichnet. Das Video kann auf den Webseiten von Eurac Research und AFI (www.afi-ipl.org) aufgerufen werden. Dasselbe gilt für die vollständige Studie.

Muss der Antrag verlängert werden?
Seit 1. März 2022 steht Familien mit zu Lasten lebenden Kindern bis zum 21. Lebensjahr ein einheitliches Kindergeld ausbezahlt von der italienischen Versicherungsanstalt NISF/INPS zu. Für arbeitsunfähige Kinder gilt keine Altersgrenze.
Jene Familien, die bereits das einheitliche Kindergeld beziehen und für die zum 28. Februar 2023 die Leistung in Auszahlung ist, brauchen keinen Antrag um Verlängerung des einheitlichen Kindesgeldes einreichen. Die Leistung wird von Amtswegen für den Zeitraum
1. März 2023 bis 29. Februar 2024 ausbezahlt. Liegt bis zum 30. Juni 2023 eine gültige ISEE-Erklärung unter 40.000 € vor, werden die erhöhten Beträge des einheitlichen Kindergeldes von Amtswegen ausbezahlt. Wird keine ISEE-Erklärung oder ab Juli 2023 gemacht, so wird der Grundbetrag von 50 € pro minderjährigen gesunden Kind an Kindergeld ausbezahlt bzw. ab dem Monat der gültigen ISEE-Erklärung unter 40.000€ der erhöhte Betrag.
Änderungen bezüglich Familienzusammensetzung, Bankdaten, Voraussetzungen für die Berechtigung, Volljährigkeit des Kindes, anerkannte Invalidität des Kindes, Arbeitstätigkeit des volljährigen Kindes, Trennung bzw. Scheidung der Eltern usw. müssen zeitnah über das Patronat an das NISF/INPS weitergeleitet werden.
Für Neugeburten sollte der Antrag innerhalb 120 Tagen ab Geburt eingereicht werden, damit Anrecht auf die Nachzahlungen ab dem 7. Schwangerschaftsmonat zustehen. Verspätete Anträge berechtigen zum einheitlichen Kindergeld ab dem darauffolgenden Monat der Antragstellung.
Erstanträge können jederzeit eingereicht werden. Wird der Erstantrag innerhalb 30. Juni des Jahres eingereicht, stehen die Nachzahlungen ab März zu. Anträge eingereicht ab 1. Juli berechtigen zum einheitlichen Kindergeld ab dem darauffolgenden Monat der Antragstellung.
Familien, die bereits das einheitliche Kindergeld beziehen, können sich auf einige Neuerungen ab Jänner 2023 freuen. Kinderreiche Familien mit 4 Kindern und mehr erhalten eine zusätzliche monatliche Zahlung von maximal 150 €. Der Betrag für Kinder unter 1 Jahr wird um 50 % erhöht. Eine Erhöhung ist auch für Familien mit mindestens 3 Kindern und mehr vorgesehen, wenn eine ISEEErklärung unter 40.000 € vorliegt und für Kinder unter 3 Jahren.
Neuerungen Pflegesicherung ab Februar 2023
Ab 1. Februar 2023 treten eine Reihe von Neuerungen in der Pflegesicherung in Kraft. Anbei die wichtigsten Neuerungen.
1. Das Pflegegeld wird grundsätzlich auf unbegrenzte Zeit ausbezahlt.
Ausnahmen sind wenn die pflegebedürftige Person eine fortgeschrittene Krankheit hat, wenn das Pflegegeld von Amtswegen zugewiesener Pflegestufe ausbezahlt wird oder wenn der Pflegebedarf auf ein akutes Ereignis zurückzuführen ist.
2. Für Anträge auf Pflegegeld, die ab dem 1. Februar 2023 eingereicht werden, erfolgt die Erhebung des individuellen Pflege- und Betreuungsbedarf grundsätzlich im Rahmen eines Gesprächs in den Räumlichkeiten des Dienstes für Pflegeeinstufung und nicht mehr zu Hause. Nur für Personen, die aus gesundheitlichen Gründen nicht zu den Räumlichkeiten des Dienstes für Pflegeeinstufung gehen können, ist ein Hausbesuch möglich. Die Notwendigkeit des Hausbesuchs muss ausdrücklich im ärztlichen Zeugnis zum Antrag des Pflegegeldes angemerkt sein.
3. Pflegebedürftige TerminalpatientInnen mit einer fortgeschrittenen Krankheit haben ab 1. Februar 2023 das Anrecht auf das Pflegegeld der 3. Stufe für die Dauer von 12 Monaten.
4. Dienstgutscheine werden ab dem zweiten Folgemonat nach Antrag um Abänderung der Dienstgutscheine gelöscht oder reduziert, sofern das Einstufungsteam eine Abänderung beschließt. Die nicht genutzten Dienstgutscheine werden ab diesem Zeitpunkt gegebenenfalls auch rückwirkend ausbezahlt.
5. Verstirbt eine Person in Erwartung der Einstufung, so kann unter folgenden Bedingungen ein Antrag auf Weiterführung des Antrags auf Pflegegeld gestellt werden: innerhalb von 60 Tagen ab Antragstellung wäre die Einstufung in den Räumlichkeiten des Dienstes oder am Aufenthaltsort der pflegebedürftigen Person möglich gewesen und die Einstufung hat aus Verschulden des

31. März 2023 Arbeitslosengeld in der Landwirtschaft für das Jahr 2022 Saisonsende 2023 Antrag um Arbeitslosengeld Naspi
Dienstes nicht fristgerecht stattgefunden. Trifft dies zu, können die Erben innerhalb von 60 Tagen ab Todesdatum einen Antrag auf Weiterführung des Antrages auf Pflegegeld stellen.
Für Anträge eingereicht nach dem 1. Februar 2023 soll die Pflegeeinstufung innerhalb von 60 Tagen erfolgen.
30. Juni 2023 Regionaler Beitrag für freiwillige Weiterversicherung Hausfrauen, Stempelmarke zu 16 €
30. Juni 2023 Beitragszahlung Pensplan bei wirtschaftlicher Notlage, z.B. Arbeitslosigkeit für das Jahr 2021 und / oder Jahr 2022. Vorheriges Abfassen der EEVE notwendig und Stempelmarke zu 16 €
30. Juni 2023 Erstantrag einheitliches Kindergeld – Assegno Unico e Universale – mit Anrecht auf Nachzahlungen ab März 2023
Nach dreijähriger Pause konnte wieder die Weihnachtsfeier für die Senioren des Dorfes stattfinden.
Organisiert wurde sie von der KVW Ortsgruppe Dorf Tirol in guter Zusammenarbeit mit der bäuerlichen Seniorenvereinigung. Zwei junge Bläser der Musikkurse eröffneten die Feier und KVW Ortsvorsitzender Hansjörg Vieider begrüßte die Geladenen. Besinnliche Texte wurden vorgetragen, Zitherspiel wechselte sich mit Bläserklängen und gemeinsam gesungenen Adventsliedern ab. Als der Saal verdunkelt und die Kerzen auf den beiden Christbäumen entzündet wurden, stimmte die Zither das „Stille Nacht“ an und alle sangen kräftig mit.
Anfang Dezember trafen sich im Vereinshaus die Senioren 60+ und KVW Ortsgruppe Mauls zu einer besinnlichen Adventfeier unter dem Motto „Gott ist nahe: Ein Stern für dich!“.
Umrahmt wurde die Feier von einer Singgruppe aus Mauls, die mit Klarinette und Gitarre begleitet wurde. Die gemeinsame Feier ist mit Kaffee, Keksen und Kuchen ausgeklungen.
Nach zwei Jahren Pause fand im neuen Bürgersaal von Moos in Passeier eine Weihnachstfeier für alle Mitbürger:innen ab 60 statt. Organisiert wurde die Feier von der Ortsgruppe Moos. Rund 40 Senioren sind der Einladung gern gefolgt. Alfons und seine Weisenbläser stimmten schon beim Betreten des Saals auf die kommenden festlichen Stunden ein. Seniorenleiterin Marialuise Kofler begrüßte die Anwesenden. Pfarrer Oswald Kuenzer hielt eine Gedenkminute für die in den letzten drei Jahren Verstorbenen ab und las dann eine Weihnachtsgeschichte vor.
Auch Bürgermeister Gotthard Gufler begrüßte alle Anwesenden: „Wir danken der KVW Ortsgruppe für ihr großes Engagement, das nicht nur diese Weihnachtsfeier ermöglicht, sondern auch die älteren Mitbürger das ganze Jahr über unterstützt und für Unterhaltung sorgt.“ Sabrinas u. Elisabeths Kindergruppe untermalten das Fest mit einem Weihnachtstheaterstück, die 9- bis 13-jährigen Kinder sangen Weihnachtslieder. Die 88-jährige Mundartdichterin Anna Lanthaler erfreute die Anwesenden mit verschiedenen Anekdoten. Gemeindearzt Dr. Alessandro Becarello kam auch dazu und feierte mit.
Die Adventsfeier der Senioren stand diesmal unter dem Thema „Das Licht im Advent“ und fand im Hotel Rosental statt. Die Ortsgruppe freute sich über die Teilnahme von 65 Personen, darunter Pfarrer Konrad Gasser und Bürgermeisterin Carmen Plaseller. Musikalisch




umrahmt wurde die Feier von 4 Frauen an der Zither, Gitarre und dem Hackbrett unter der Leitung von Margit Nagler. Beim Anzünden des Adventskranzes wurde ein Adventsgedicht verlesen. Die Geschichte „Die Kerze am Fenster“ sollte zur Gemeinsamkeit aufrufen. Gemütlich ging es weiter mit Weihnachtsgebäck und Tee und dem Genießen der stimmungsvollen Adventsatmosphäre.
Bei einer üppigen Marende, Suppe, Kaffee und Kuchenbuffet tauschten sich die Senioren über Vergangenes und Aktuelles aus. Jeder Teilnehmer bekam einen Zelten als Aufmerksamkeit überreicht. Allen, die zu dieser schönen Feier beigetragen haben, ein großes, herzliches Dankeschön.
Ein großes Dankeschön an die KVW Ortsgruppe St. Leonhard/Passeier für die alljährliche Organisation und Durchführung der Nikolausfeier. Die Spenden von Privatpersonen und Hotels in Höhe von 1.670 € geht zu Gunsten bedürftiger Familien und „St. Leonhard hilft“.
Im August letzten Jahres feierte die Ortsgruppe das 30-jährige Bestehen. Im feierlichen Gottesdienst mit Seniorenseelsorger Josef Torggler wurde für die vergangenen drei Jahrzehnte gedankt und der verstorbenen Mitglieder gedacht. Nach dem Umtrunk und Museumsbesuch fanden auf dem Festplatz das Mittagessen und der „offizielle“ Teil statt. Wirklich viele Senioren sowie Ehrengäste waren gekommen. Neben den Vertretern der Seniorenvereinigung, des KVW und der Gemeinde war auch Flora Man-
tinger unter den Ehrengästen. Sie soll besonders erwähnt werden, da sie die einzige noch lebende Gründerin der Gruppe ist und ihr als erster Ortspräsidentin (sie leitete die Gruppe 26 Jahre lang) der herzliche Dank aller gebührt. Als Andenken haben die Mitglieder noch einen blauen Schurz mit Logo und „Senioren Teis – 30 Jahre“ darauf erhalten.



Gemeinsam mit den Wipptaler Kindern ging es auch für 6 Flüchtlingskinder aus der Ukraine auf den Rosskopf. Die Ortsgruppe Wiesen organisierte die Teilnahme für die Grundschüler. Damit diese Aktion überhaupt zustande kam, zogen auch die Gemeindeverwaltung von Pfitsch und Sterzing, die Bezirksgemeinschaft, die Rosskopfseilbahn sowie die Skischule Sterzing an einem Strang und unterstützen die Initiative. Die komplette Skiausrüstung stellte der Skiverleih zur Verfügung und sogar ein Weih-
nachtsgutschein für jedes Kind gab unser Wipptaler Kindergeschenkehändler (Pfiff Toys) dazu. „Vergelts Gott“ allen für die super Zusammenarbeit.
Die Kinder zeigen viel Freude und Spaß beim Skifahren. Die Skilehrer:innen gaben ihr Können mit viel Geduld und Ausdauer den Kindern weiter. Diese haben bereits nach wenigen Stunden große Fortschritte gemacht und zudem Freundschaften mit Wipptaler Kindern geschlossen.
Das Sternsingen in Weitental wurde in diesem Jahr von ganz besonderen Klängen begleitet. Die drei Kindergruppen aus der fünften Klasse der Grundschule hatten mit ihren Lehrpersonen nämlich einen Rap einstudiert, den sie gemeinsam mit anderen Texten und Liedern mutig vortrugen. So zogen sie von Haus zu Haus, verkündeten die Weihnachtsbotschaft, verteilten Weihrauch und konnten den beachtlichen Spendenbetrag von 5.368,71 € für Kinder in Tansania (Ostafrika) sammeln. Zum Abschluss der gelungenen Aktion hatten die Sternsinger am sechsten Januar noch die Gelegenheit den Festgottesdienst mit Bischof Ivo Muser mitzugestalten, welcher die-sen Tag heuer in Weitental verbrachte. Der KVW-Weitental möchte hiermit nochmal all jenen von Herzen danken, die das Sternsingen unterstützt und sich an der Spendenaktion beteiligt haben.

Die Herbstwallfahrt führte 40 Teilnehmer:innen von der Ortsgruppe Lüsen nach Maria Trens.
Der Theologe Martin Ellemunt und seine Familie überraschten uns mit einer eindrucksvollen Gestaltung der Andacht: der Rosenkranz, vorgetragen von seiner Gattin, wurde von Martin und Tochter, teils mit Geige, teils mit Gitarre und Orgel musikalisch umrahmt. Dir Gruppe kehrte in Trens zur Marende ein, bevor es wieder nach Hause ging.

Der KVW Durnholz hält seit einigen Jahren für die Mitglieder, die einen runden Geburtstag gefeiert haben, eine kleine Überraschung bereit. Heuer erhielten
11 Personen im Rahmen der Ausgabe der Mitgliedsausweise eine selbst genähte Schürze mit Namen. Herzlichen Glückwunsch an die Geburtstagskinder und ein großes Dankeschön der Näherin Agata, der Stickerin Barbara und allen Mitgliedern für die Treue zum KVW.

Das traditionelle Preiswatten der KVW Ortsgruppe Meran konnte heuer wieder im Kimm stattfinden. Rund 104 Teilnehmern:innen waren dabei und freuten sich über die tolle Organisation und die schönen Sachpreise. Der Erlös geht an den Verein Adlatus und an die Essenstafel. Ein großes Kompliment an Obmann Siegfried Gufler und seinen gesamten Ausschuss für den gelungenen Nachmittag.


Im Alltag kann jeder einmal in eine Mobbingsituation geraten oder auch zum Tätern werden. Aus diesem Grund wurden ein Vortrag für Eltern und Pädagogen sowie zwei Workshops für Grundund Mittelschüler:innen veranstaltet. Diese wurden von den Referent:innen von Protactics durchgeführt. Dabei boten sich den Teilnehmenden verschiedene Möglichkeiten. Dazu gehört unter anderem sich rundum zu informieren, zu lernen Situationen besser einzuordnen, die Kinder und Jugendlichen er-

fahren zu lassen wo Mobbing anfängt und was man gegenwirkend unternehmen kann, wie man Grenzen setzen kann, wie man sich Hilfe sucht und andere unterstützt. Alle Beteiligten waren begeistert. Wir bedanken uns bei Protactics für die gute Zusammenarbeit und die kompetente Vermittlung dieses schwierigen, aber wichtigen Themas. Eine Zusammenarbeit zwischen dem KVW Meransen, der Bibliothek Mühlbach/Meransen und dem Jugenddienst Unteres Pustertal.

Zum ersten Mal veranstaltete die Ortsgruppe Pfunders einen Töpferkurs für Kinder. Sofort war die Begeisterung groß und so gelang es Sarah Volgger vom Label heartmade-keramik.com, den Kindern mit viel Geduld und Geschick das Töpfern beizubringen. Mit viel Liebe entstanden daraus tolle Unikate.


Bei den zahlreichen Aktivitäten des KVW St. Michael für die Dorfgemeinschaft sind Schürzen ein praktischer Schutz in allerlei Situationen. Als KVW helfen wir bei den verschiedenen Umtrunken und Feierlichkeiten der Pfarrei, beim Suppensonntag genauso wie bei Jubiläen und Kirchtagen. Ebenso gibt es Eigenveranstaltungen wie Seniorentage, die Ferientage auf Matschatsch oder auch die Weihnachtfeier für Mitmenschen mit Behinderung bei denen eine Schürze gebraucht wird. Daher haben wir im Ausschuss beschlossen, einen gleichen Schurz für alle Helfer:innen anzuschaffen. Das besondere Angebot der Firma Stickprofi im Pillhof half uns, diesen Plan umzusetzen. Somit werden wir anlässlich der Gründung der Seelsorgeeinheit Überetsch im März unsere neuen Schürzen zum ersten Mal umhängen und freuen uns auf Eure Rückmeldungen.
Es ist ein alter, bekannter Brauch, dass am Fest des heiligen Apostels Johannes in den Kirchen unseres Landes Wein gesegnet wird. Um diese Tradition zu fördern, hat das Kloster Neustift in diesem Jahr einen eigenen Johanneswein mit entsprechender Etikette produziert. Gemeinnützige Vereine konnten sich an der Aktion beteiligen und den Johanneswein relativ günstig erwerben. So hat auch der KVW Weitental 50 Flaschen dieses Weines erworben und gegen eine freiwillige Spende an die Kirchenbesucher verteilt.

Wir jedes Jahr füllte sich für die Jahreshaupteversammlung der Ortsstelle Steinegg Gummer der Saal mit den vielen Mitgliedern. Cilli Wenter präsentiert die vielfältigen Tätigkeiten der Gruppe anhand von Fotos. Als Gastredner ging Herr Martin Schwienbacher auf das aktuelle Thema „Betrügereien an Senioren und Tipps gegen Einbruch“ ein. Margareth Fink vom Vorstand sprach über das KVW Jahresthema und teilte nochmals mit, dass das Patronat unter Personalmangel leide. Die Gemeindereferentin Martina Lantschner informierte über die Möglichkeit den Psychologen Dr. Ausserer unbürokra-
tisch zu kontaktieren und über den Umbau des Seniorenwohnheimes.
Folgende Mitglieder wurden geehrt: für 25 Jahre: Ottilia Rieder, Brigitta Mahlknecht, Luisa Lantschner und Clothilde Lantschner; für 50 Jahre Mitgliedschaf Peter Rieder.


Im neuen Ausschuss sind Evi Auer, Rosmarie Tschager, Theresia Oberberger, Adelinde Pixner, Bernhard Vieider und Brigitta Mahlknecht vertreten. Verdiente Mitarbeiter bzw. Ausschussmitglieder wurden mit einem Geschenk verabschiedet.
Im Dezember feierte der Seniorentreff Weitental sein 25jähriges Jubiläum. Man traf sich beim Moar in Huntsdorf zum gemeinsamen Essen und Feiern. Gründungsmitglied und seitdem Vorsitzender, Thomas Unterkircher richtete in seiner Rede Gruß- und Dankesworte, an alle Anwesenden. Dabei gestaltete er einen interessanten Rückblick über die vergangenen 25 Jahre. Gegründet wurde der Verein im Jahr 1997. Seitdem gab es 304 Treffen, 33 Halbtagesfahrten und 51 Vorträge. Zu den Gratulanten gesellten sich auch Bürgermeister Walter Huber und sein Stellvertreter Walter Lamprecht, sowie Fraktionsvorsteher Anton Gasser, Pater Albin Peskoller, Bildungsausschuss-Leiterin Elsa Lamprecht und KVW-Obmann Josef Engl. Ein besonderer Dank galt den freiwilligen Helfern, besonders Regina, der Frau vom Vorsitzenden Thomas. Die Feier wurde musikalisch umrahmt.
 ST. MICHAEL
ST. MICHAEL
26 Senioren von Barbian machten ihren Herbstauflug in das schöne Schmierntal. Wieder einmal über den Brenner fahren, das war schon toll. Dann ging es hoch hinauf bis sich das Tal öffnete und schöne, ebene Weideflächen kamen zu Tage. Die Berge zum Greifen nahe, sahen wir viele Ziegen und Grauvieh weiden und es herrschte eine wunderbar Ruhe. Alle waren begeistert.

Du fragst dich wie schwitzen im Wasser geht? Dann komm das nächste Mal zur Wassergymnastik im Alpinpool und der die Ortsgruppe Meransen zeigt es dir! Das Element Wasser bietet unzählige Möglichkeiten: Kraft, Ausdauer, Beweglichkeit und Koordination- all dies wird besonders rücken- und gelenkschonend trainiert. Die Wassergymnastik mit Sabrina de Coll eignet sich für alle Altersgruppen und Fitnesslevel.
Wir freuen uns über viele motivierte Teilnehmer und wenn du beim nächsten Training auch mitmachen möchtest sende einfach eine E-Mail an: meransen@kvw.org
Im Dezember fand im neuen Medienraum der Grundschule die traditionelle Adventfeier statt. Viele Mitglieder, Senioren und Alleinstehende aus dem Dorf waren unserer Einladung gefolgt. Mit wunderschönen adventlichen Weisen erfreuten uns die Geschwister Gasser aus Onach mit ihrem Vater. Pfarrer Paul Schwienbacher sprach Worte der Besinnung und unser Talchronist Peter Seiwald erzählte uns Interessantes aus der Geschichte des Gsiesertals! Bei Tee mit Punsch, Weihnachtsgebäck und einem Gläschen Wein verging die Zeit wie im Flug. Unsere Geburtstagsjubilare wurden noch mit einem kleinen Präsent überrascht. Zum Abschluss gab es noch für alle Anwesenden ein kleines, liebevoll verpacktes Geschenk.
Der KVW ist eine organisierte Bewegung von arbeitenden Menschen, die sich für eine gemeinsame Sache einsetzen. Vorstandsmitglied Herbert Schatzer ging in seinem Referat bei der Ortsversammlung in Raas auf „seine persönliche KVW Geschichte“ ein und appellierte an den Mut der Anwesenden selbst im Ortsausschuss mitzuarbeiten. Dann seien ihnen Dankbarkeit der Dorfbevölkerung und eigene Genugtuung sicher.
Bei der kürzlich stattgefundenen Vollversammlung der Ortsgruppe Pfalzen wurden einige Mitglieder für ihre langjährige Mitgliedschaft im KVW geehrt. Für die 70-jährige Mitgliedschaft erhielten Frau Aloisia Althuber Grunser und Herr Alois Bachmann die goldene Anstecknadel und eine Ehrenurkunde. Frau Anni Zwischenbrugger Mittich und Herr Heiner Nicolussi-Leck erhielten ein Urkunde für 50 Jahre Mitgliedschaft im KVW.
Die KVW Senioren 60+ in Aktion von Mauls treffen sich jeden zweiten Donnerstag im Monat im Vereinshaus. Diesmal am 09. Februar, war es sehr interessant und lehrreich. Frau Gerlinde Pichler, Bewegungsleiterin, brachte unsere Senioren mit ihrem abwechslungsreichen Programm so richtig in Stimmung. Es tat einfach gut – für Körper, Geist und Seele. Anschließend unterhielten wir uns bei Kaffee und Faschingskrapfen. Nach ein paar Karterlen gingen alle wieder zufrieden nach Hause.




 BARBIAN
BARBIAN
Ende Januar 2023 fand auf Einladung des KVW-Ortsausschusses Moos in Passeier ein Vortrag mit Dr. Peter Matzneller, Rheumatologe am Krankenhaus in Meran und Schlanders, im neuen, bestens ausgestatteten Bürgersaal statt. Dr. Matzneller referierte auf anschauliche Art und Weise über das Thema „Rheuma – Was ist das eigentlich?“ Mit ausreichendem Bildmaterial ging Dr. Matzneller auf die verschiedenen Erkrankungen des rheumatischen Formenkreises ein. Der Rheumatologe verdeutlichte in diesem Vortrag sehr genau den Unterschied zwischen Arthrose und Arthritis. Auch wies er darauf hin, dass der erste Ansprechpartner bei Auffälligkeiten diesbezüglich der Hausarzt sei, der dann die nötigen, weiteren Schritte einleitet. Im Anschluss an seinen Vortrag beantwortete Dr. Matzneller noch die aufkommenden Fragen des Publikums. Im Rahmen der Veranstaltung stellten die Vorstandsmitglieder der RheumaLiga, Birgit Kaschta und Christine Peterlini, auch die Bewegungstherapiekurse des Vereins vor. „Wir möchten über Rheuma aufklären und unseren betroffenen Mitmenschen helfend zur Seite stehen. Wir laden alle Betroffenen ein, die Bewegungstherapiekurse der Rheuma-Liga zu besuchen. Die geschonte Bewegung trägt zu einer besseren Bewältigung der Erkrankung bei. Egal ob Wassergymnastik, Trockengymnastik, Yoga: Bewegung macht Spaß und tut gut“, so abschließend der Präsident der Rheuma-Liga Günter Stolz, Christine Peterlini und Birgit Kaschta.
Das mittlerweile traditionelle Grillfest für Senioren und Alleinstehende ist auch letztes Jahr zur Freude aller Anwesenden gut gelungen. Bei herrlichem Wetter, flotter Musik und fröhlicher Stimmung freuten wir uns in netter Gesellschaft zu sein. Der köstliche Grillteller und ein gutes Gläschen Wein durfte nicht fehlen. Es gab viel zu erzählen und wie immer wurde fleißig das Tanzbein geschwungen. Ein Dank geht an die Fraktionsverwaltung für die finanzielle Unterstützung.

Für die jünger gebliebenen Senioren gab es letzten Sommer die monatlichen Wanderungen mit unserem „Wanderführer“ Franz. Er verstand es sehr gut, unsere Kondition auszutesten und gegebenenfalls die Touren auch etwas kürzer zu machen. Wir konnten sehr viele schöne Orte unserer Heimat kennen lernen und uns über die wunderbare Natur freuen. Wir alle sind uns einig: Gemeinschaft macht Spaß und tut uns gut!
Bei unserer Rabattliste in der letzten Ausgabe des Kompass ist uns ein Fehler unterlaufen. Unsere Rabattliste war nicht vollständig. In folgenden Geschäften erhält man gegen Vorlage des Mitgliedsausweises ebenso einen Preisnachlass.
KATHOLISCHER VERBAND DER WERKTÄTIGEN VFG
Beratung. KVW Senioren. T 0471 309 175
Reisen: Begegnung. Erholung. KVW Reisen GmbH. T 0471 309 919
Wohnen: Genossenschaft. Senioren. Arche im KVW. T 0471 061 300
Solidarität: Unterstützung. Tatkraft. KVW Hilfsfonds. T 0471 309 181
Soziale Vor- und Fürsorge: Information. Beratung. Patronat KVW/ACLI. T 0471 978 677

Hebammen: Weiterbildung. Austausch. Berufsgruppe Hebammen im KVW. T 0471 300 214

Verwitwete und Alleinstehende: Mut. Halt. Interessensgruppe für Verwitwete und Alleinstehende. T 0471 300 214
Südtiroler in der Welt: Kontakte. Rückhalt. Arbeitsstelle für Heimatferne.
T 0471 309 176
Verband: Vor Ort. Mitgestalten. KVW Ortsgruppen. T 0471 300 214
Zeitschriften: “Kompass” (Abo 1 Euro im Mitgliedsbeitrag enthalten)
“Heimat & Welt”
Den Datenschutzhinweis des KVW finden Sie unter www.kvw.org.
Mitgliedsbeitrag:
Für unsere jüngsten Bildungsfreunde haben wir im Sommer 2023 ein abwechslungsreiches Programm geplant, bei dem der gemeinsame Spaß und die Freude am Lernen im Mittelpunkt steht. Von Sport- über Sprachangebote bis hin zu Abenteuer-und Erlebniscamps ist auch diesmal für diverse Altersgruppen und Interessen etwas dabei.
Das gesamte Sommerangebot finden Sie aktualisiert auf unserer Webseite bildung.kvw.org
Sommercamps 2023
Gemeinsam kreativ mit Ton, Farbe und mehr
Veranstalter: KVW Ortsgruppe St. Ulrich
Zielgruppe: MittelschülerInnen
Zeit: Mo. 10.07.2023 - Fr. 14.07.2023
Dauer: 5 Vormittage, 9.00 Uhr - 12.00 Uhr
Ort: St. Ulrich, Pfarrhaus, St. Ulrich
Referentin: Claudia Verra, Lehrperson, Kunsttherapeutin, St. Ulrich in gröden
Gebühr: Euro 78,00, plus Euro 20,00 für Materialspesen
Hinweis: Information und Anmeldung bei Claudia Verra, Tel. 338 4848676
Mitzubringen: Vormittagsjause, Trinkflasche, angemessene Kleidung und Schürze, große Kartonschachtel
Kompetenzen für die Zukunft!
Körper & Geist - Stärke dein Ich
An den Vormittagen lernen die Jugendlichen Inhalte zu programmieren, ganz nebenbei werden Grundkenntnisse in Mathematik, logisches und strukturiertes Denken gefestigt und erste Informatikkenntnisse erlangt. Beim Selbstverteidigungskurs am Nachmittag wird das Selbstbewusstsein gestärkt und Selbstverteidigungstechniken erlernt.
Zielgruppe: MittelschülerInnen bis AbgängerInnen der 1. Klasse Oberschule
Zeit: Mo. 24.07.2023 - Fr. 28.07.2023
Dauer: 5 Tage, 8.30 Uhr - 15.30 Uhr
Ort: Meran, KVW Kursraum 84, Otto-HuberStraße 84
Referenten: Jürgen Laner Leiter, Informatiker, Mühlbach, Franz Meinrad Gluderer, Trainer für Kampfsport und Selbstverteidigung, Meran
Gebühr: Euro 120,00
Mitzubringen: eigenes Smartphone (bitte bei Anmeldung Betriebssystem mitteilen), Tagesproviant (Trinken, Pause, Mittagessen), sportliche Kleidung
Unter den Sternen - Erlebnis- und Abenteuercamp in Langtaufers
Ihr erlebt auf der Berghütte Maseben auf 2.200 Metern einen Abenteuerurlaub ganz ohne Eltern. Übernachtung und Verpflegung auf der Berghütte Maseben, Spaß beim Wandern auf Almen, die Natur entdecken, Astronomie erfahren und hautnah erleben. Schlechtwetterprogramm vorgesehen; das Programm wird an die Kondition der Gruppe und den Wetterverhältnissen angepasst.
Zielgruppe: 9 bis 12-jährige
(Jahrgang 2011 bis 2014)
Zeit: Mo. 21.08.2023 - Do. 24.08.2023
Dauer: 4 Tage, 8.30 Uhr - 17.30 Uhr
Ort: Graun in Vinschgau, LangtaufersBerghütte Maseben
Referenten: Wolfgang Thöni, Graun i. Vinschgau, Fachreferent / Fachreferentin
Gebühr: Euro 230,00, mit Übernachtungen auf der Berghütte Maseben und Verpflegung, Förderung für Mitglieder der EbK Mitzubringen: Kofferpackliste wird zugesandt
Unter den Sternen - Naturwochenende für Eltern mit Kind/ern
Ihr seid den Sternen ganz nah, auf der Berghütte Maseben in Langtaufers auf 2.200 Metern und erlebt ein Wochenende ganz im Sinne der Familie, mit Übernachtung und Verpflegung. Zeit für die Familie... es wird gewandert, gespielt und gebastelt... und alles in der freien Natur.
Zielgruppe: Eltern mit Kindern im Alter von 8 bis 12 Jahren

Zeit: Fr. 25.08.2023 - So. 27.08.2023
Dauer: 3 Tage, 8.30 Uhr - 17.30 Uhr
Ort: Graun in Vinschgau, LangtaufersBerghütte Maseben
Referent: Wolfgang Thöni, Graun i. Vinschgau
Gebühr: Euro 280,00 / Euro 60,00 jedes weitere Kind / Euro 80,00 zweiter Elternteil, für einen Erwachsenen mit einem Kind, mit Übernachtung und Verpflegung auf der Berghütte Maseben (jedes weitere Kind Euro 60,00, zweiter Elternteil Euro 80,00), Förderung für Mitglieder der EbK
Mitzubringen: Kofferpackliste wird zugesandt
Kreativität - Sprache - Spaß ohne Grenzen
Zielgruppe: Kinder im Alter von 7 bis 11 Jahren
Zeit: Mo. 26.06.2023 - Fr. 30.06.2023
Dauer: 5 Vormittage, 8.00 Uhr - 12.00 Uhr
Ort: Sterzing, Atelier Ckrealis und Elki Garten
Referentin: Barbara Baldessari Unterrainer, Kunsttherapeutin, Sterzing
Gebühr: Euro 95,00 / Euro 90,00 für
Geschwister, plus Euro 15,00 Materialspesen, Förderung für Mitglieder der EbK
Hinweis: Kinder im Alter von 7 bis 11 Jahren
Mitzubringen: Freude und Kreativität
Action pur: Rafting & Hochseilgarten
Zielgruppe: Kinder im Alter von 8 - 12 Jahren
Zeit: Mo. 28.08.2023 - Fr. 01.09.2023
Dauer: 5 Vormittage, 8.00 Uhr - 12.00 Uhr
Ort: Freienfeld, Sportzentrum Stilfes und Hochseilgarten Sterzing
GmbH Tiger, Freienfeld
Gebühr: Euro 115,00 / Euro 110,00 für Geschwister
Hinweis: Kinder im Alter von 8 bis 12 Jahren
Mitzubringen: Handtuch, Badebekleidung, evtl. Funktionsunterwäsche, die unter dem Neoprenanzug angezogen wird. Achtung, es wird alles nass! Für den Hochseilgarten
Kletter- oder Fahrradhelm. Die Ausrüstung stellt die Tiger GmbH zur Verfügung.
Fotocamp - fotoGRAFICamente
Zielgruppe: Kinder im Alter von 10 bis 14 Jahren
Zeit: Mo. 31.07.2023 - Fr. 04.08.2023
Dauer: 5 Vormittage, 8.30 Uhr - 12.00 Uhr
Ort: Sterzing, KVW Kursraum, Brennerstraße 14b
Referenten: Francesco Sommacal, Brenner, Nic Mair, Brenner
Gebühr: Euro 115,00 / Euro 110,00 für
Geschwister, Förderung für Mitglieder der EbK
Hinweis: Kinder im Alter von 10 bis 14 Jahren
Mitzubringen: eigene Kamera (Digitalkamera) mit Bedienungsanleitung, Freude und Kreativität
Allerlei Italienisch
Verschiedene Zeiträume
Dauer: jeweils Mo-Fr, 9.00 Uhr – 12.00 Uhr
Ort: Pustertal, verschiedene Dörfer
Kochen auf Italienisch

In Zusammenarbeit mit SLASH EO Du liebst es zu kochen? Du möchtest Kochgrundlagen kennenlernen, die du zuhause auch alleine umsetzen kannst?
Gemeinsam mit einer Italienischlehrerin werdet ihr Rezepte schreiben, kochen und einkaufen. Das Beste daran - du kannst am Ende natürlich alle Leckereien mit deinen Freunden vernaschen.
Zielgruppe: Mittelschüler
Zeit: Mo. 17.07.2023 - Fr. 21.07.2023
Dauer: 5 Vormittage, 8.00 Uhr - 12.00 Uhr
Ort: Gais, Feuerwehrhalle
Un tuffo nell’italiano
In Zusammenarbeit mit alpha beta piccadilly Zielgruppe: Kinder der 4.5. Klasse Grundschule + 1. Klasse Mittelschule
Zeit: Mo. 21.08.2023 – Fr. 01.09.2023
Dauer: 10 Tage, 9.00 Uhr – 16.00 Uhr
Ort: Brixen, Acquarena Brixen
Gebühr: Euro 290,00 inkl. Lehrmaterial, Eintritt und Mittagessen; Euro 270,00 Frühbucherpreis bei Anmeldung innerhalb 31.03.
Englisch & Schwimmen
In Zusammenarbeit mit alpha beta piccadilly
Dauer: 10 Tage, 9.00 Uhr – 16.00 Uhr
Ort: Brixen, Acquarena Brixen
Gebühr: Euro 290,00 inkl. Lehrmaterial, Eintritt und Mittagessen; Euro 270,00 Frühbucherpreis bei Anmeldung innerhalb 31.03.
Zielgruppe: Kinder der 4. 5. Grundschule + 1. Mittelschule
Zeit: Mo. 26.06.2023 – Fr. 07.07.2023
Zielgruppe: Kinder der 1. 2. 3. Grundschule
Zeit: Mo. 21.08.2023 – Fr. 01.09.2023
Deutsch & Schwimmen
In Zusammenarbeit mit alpha beta piccadilly
Zielgruppe: Kinder der 1. 2. 3. Grundschule

Dauer: 10 Tage, 9.00 Uhr – 16.00 Uhr
Ort: Brixen, Acquarena Brixen
Gebühr: Euro 290,00 inkl. Lehrmaterial, Eintritt und Mittagessen; Euro 270,00 Frühbucherpreis bei Anmeldung innerhalb 31.03.
Zeit Kurs 1: Mo. 26.06.2023 – Fr. 07.07.2023
Zeit Kurs 2: Mo. 31.07.2023 – Fr. 11.08.2023
…. und viele weitere Sommercamps finden Sie auf unserer Webseite bildung.kvw.org
ERHOLUNGS reisen
8 TAGE
3. bis 10. Mai 2023
Norbert Spornberger
PREIS 870 € / 860 €
8 TAGE
20. bis 27. September 2023
Martha Pattis
PREIS 870 € / 860 €
8 TAGE
25. Mai bis 1. Juni 2023
Margit Schwenk
PREIS 970 € / 960 €
8 TAGE
01. bis 8. Juni 2023
Willy Runggaldier
PREIS 970 € / 960 €
11 TAGE
26. Mai bis 5. Juni 2023
Gerlinde Aukenthaler
PREIS 830 € / 820 €
14 TAGE
5. bis 18. Juni 2023
Martha Pattis
PREIS 1.040 € / 1.030 €



10 TAGE
6. bis 15. Juni 2023
Anna Maria Obrist
PREIS 995 € / 985 €
10 TAGE
15. bis 24. Juni 2023
KVW Begleitperson
PREIS 995 € / 985 €
8 TAGE
25. Juni bis 2. Juli 2023
Konrad Gatterer
PREIS 1.030 € / 1.020 €
8 TAGE
2. bis 9. Juli 2023
Daniela Cavagnan
PREIS 1.030 € / 1.020 €
10 TAGE
11. bis 20. September 2023
Monika Malfertheiner
PREIS 1.130 € / 1.1120 €
12 TAGE
18. bis 29. Juni 2023
Ivone Stimpfl
PREIS 895 € / 885€
9 TAGE
29. Juni bis 7. Juli 2023
Rosa Obexer
PREIS 750 € / 740€
Weitere Angebote ohne Reisebegleitung in Riccione auf Anfrage!
Foto: Weissenseeinformation

6 TAGE
18. Juni bis 23. Juni 2023
Norbert Spornberger
PREIS 730 € / 720 €
KULTURreisen
22. bis 25. April 2023
Dieter Brugger
PREIS 780 € / 770 € für Mitglieder
14. bis 18. Mai 2023

Gerlinde Aukenthaler
PREIS 970 € / 960 € für Mitglieder
11. bis 16. April 2023
Tanzen am Gardasee
Barbara Dietl Unterholzner
PREIS 580/ 570 €
23. bis 28. April 2023
Wandern in der südlichen Toskana
Hermann Pfeifhofer
PREIS 940 € / 930 €
29. April bis 6. Mai 2023
Ischia – grüne Berge und heiße Quellen


Gerlinde Aukenthaler
PREIS 1.130 € / 1.120 €
30. April bis 7. Mai 2023
Sardinien – archaische Landschaften der Barbagia
Günther Gramm
PREIS 1.290 € / 1.280 € für Mitglieder+ Richtpreis Flug 200 €
7. bis 14. Mai 2023
Tanzen und Wellness in Abano
Ingeborg Stecher
PREIS 995 € / 985 €
7. bis 11. August 2023
Wellness und Wandern im Ötztal

Sepp Agreiter
PREIS 620 € / 610 € für Mitglieder
17. bis 24. Juni 2023
Basenfasten und Wandern im grünen Pustertal
Paula Holzer
PREIS 880 € / 870 €
24. Juni bis 1. Juli 2023
Monti Sibillini – Wandern auf dem Blumendach Italiens

Dieter Brugger
PREIS 1.250 € / 1.240 € für Mitglieder
1. bis 5. Juli 2023
Montafon – Wandern im südlichsten Alpental Vorarlbergs
Michael Berger
PREIS 750 € / 740 € für Mitglieder
2. bis 7. Juli 2023
Valle Maria – Natur und Ursprünglichkeit
Günther Gramm
PREIS 1.030 € / 1.020€ € für Mitglieder
Information & Anmeldung
KVW Reisen GmbH
Pfarrplatz 31 39100 Bozen

Tel. 0471 309 919 reisen@kvw.org
Eventuelle Anmeldung auch in allen Bezirksbüros www.kvw.org
Seit 1. Jänner kann für die verschiedensten Energiesparmaßnahmen und den Einsatz von erneuerbaren Energiequellen wieder um einen Landesbeitrag angesucht werden. Mit Jahresbeginn wurden einige Neuerungen eingeführt.

Für Gebäude oder Baueinheiten, die vor dem 12. Jänner 2005 gebaut wurden und an denen energetische Sanierungsmaßnahmen durchgeführt werden, können einen Beitrag im Ausmaß von 40% bis 80% der zulässigen Kosten in Anspruch nehmen.
Gefördert werden die verschiedensten Wärmedämmmaßnahmen, wie die Wärmedämmung von Außenmauern, Dächern, obersten und untersten Geschossdecken, sowie Terrassen und Lauben. Auch für die Dachbegrünung und die Mehrkosten für eine hinterlüftete Fassade gibt es einen Beitrag. Außerdem kann für den Einbau einer Lüftungsanlage mit Wärmerückgewinnung und die Durchführung eines hydraulischen Abgleiches ein Beitrag beantragt den. Ebenso kann im Rahmen der Sanierung auch für den Einbau einer gemeinschaftlichen Photovoltaikanlagen in einem Kondominium ein Beitrag in Anspruch genommen werden.
Hydraulischer Abgleich.
Einfach erklärt
Der hydraulische Abgleich ist ein besonders wirksames Verfahren, um eine Heizanlage zu optimieren. Vereinfacht ausgedrückt versteht man unter dem Begriff hydraulischer Abgleich, die fachgerechte Einregulierung einer Heizanlage. Der hydraulische Abgleich sorgt dafür, dass durch alle Heizkörper bzw. die Boden-, Wand- oder Deckenheizung, die richtige Wassermenge fließen kann. Je nach Heizanlage sind dadurch Energieeinsparungen zwischen 2 und 8% möglich.
Für die genannten Maßnahmen können Beiträge zwischen 40% und 80% auf die zulässigen Kosten gewährt werden.
ɏ 80% für Kondominien (mind. 5 Baueinheiten und Eigentümer), sofern das Gebäude als KlimaHaus B oder R zertifiziert wird
ɏ 60% für alle anderen Gebäude, die eine Zertifizierung als KlimaHaus B oder R erreichen
ɏ 40%, sofern es sich um einzelne Baueinheiten mit der Zertifizierung R handelt oder um Gebäude, welche die Zertifizierung C erreichen oder für Gebäude unter Denkmal- und Ensembleschutz
Schritte für Schritt zur Landesförderung
Schritt 1: Entscheidung treffen, welche Sanierungsmaßnahmen umgesetzt werden.
Schritt 2: KlimaHaus-Berechnung durchführen, um einschätzen zu können ob die Sanierungsmaßnahmen ausreichend sind, um den Beitrag beantragen zu können (nicht überall erforderlich).
Schritt 3: Einholung von Kostenvoranschlägen.
Schritt 4: Innerhalb 31. Mai muss der Antrag auf Gewährung des Landbeitrages gestellt werden. Diesem müssen der Kostenvoranschlag und das technisch
Datenblatt beigelegt werden. Je nach Maßnahme sind weitere Dokumente erforderlich.
Schritt 5: Abwarten bis die Zusage von Seiten des zuständigen Landesamtes eingeht und dann mit den Sanierungsarbeiten beginnen.
Auch Einzelmaßnahmen
werden gefördert
Das Land vergibt nicht nur für die energetische Gesamtsanierung Beiträge, sondern auch für einzelnen Maßnahmen. Je nach Maßnahme liegt die Förderhöhe hier zwischen 30% und 40% auf die zulässigen Kosten.
40% erhält man für:
ɏ Die Durchführung eines hydraulischen Abgleiches an einer für bestehenden Heizund Kühlanlagen (Baukonzession vor dem 01. Jänner 2013)
ɏ Den Austausch einer zentralen Öl- und Gasanlage (Baujahr vor 2007) in Mehrfamiliengebäuden (mind. 5 Baueinheiten und Eigentümer)
ɏ Den Einbau einer thermischen Solaranlage
ɏ Den Einbau von elektrischen Wärmepumpen gleichzeitig mit einer Photovoltaikanlage (KlimaHaus C oder R)
30% gibt es für:
ɏ Den Einbau einer Speicherbatterie für netzgebundene Photovoltaikanlagen
Weitere Beiträge werden vergeben für den Einbau von Photovoltaik- und Windkraftanlagen, sofern keine Anschlussmöglichkeit an das öffentliche Stromnetz besteht. Alternativ zu den Landesbeiträgen gibt es für die verschiedenen Maßnahmen auch auf staatlicher Ebene eine Reihe von Möglichkeiten, um in den Genuss von finanziellen Anreizen zu kommen, wie die Steuerabzüge für Sanierungsmaßnahmen oder die Förderung für den Einsatz erneuerbaren Energien (Conto termico).
Jeder Hausbau und jede Gebäudesanierung ist eine große Herausforderung und stellt Baufrauen und Bauherrn vor einen Berg voller Fragen. Produktunabhängige Fachleute informieren über energiesparendes Bauen und Sanieren, Heizsysteme, Förderungen, u.v.m. Sie geben Einblicke in das komplexe Baugeschehen und geben Tipps wie mit Freude und Gelassenheit dem künftigen Bau- und Sanierungsvorhaben entgegengesehen werden kann.
STEUERABZÜGE FÜR SANIERUNGSARBEITEN
50%, 65%, 75%, UND 90%
MITTWOCH, 29. MÄRZ
ɏ Steuerabzüge für Instandhaltungs-, Sanierungs-, Umbau- und Wiedergewinnungsarbeiten (50%)
ɏ Steuerabzüge für energetische Sanierungsmaßnahmen (50%, 65%, 75%)
HEIZSYSTEME IM VERGLEICH
MITTWOCH, 26. APRIL
ɏ Heizsysteme im Vergleich
ɏ Wärmeabgabesysteme: Wand-, Bodenheizung, Heizkörper
ɏ Solaranlagen für Warmwasser und Heizung
ɏ Photovoltaik
ɏ Lüftungsanlagen
ES AUCH DIE MÖGLICHKEIT EINER INDIVIDUELLEN ENERGIE-, BAUUND SANIERUNGSBERATUNG DURCH DIE PRODUKTUNABHÄNGIGEN FACHBERATER DES ENERGIEFORUM SÜDTIROL.
Referentin: Christine Romen, Energie- und Bauberaterin und Bildungs- und Energieform (AFB)

Kosten: 55 Euro inkl. MwSt. pro Abendeinheit
Die Anmeldung ist erst mit Einzahlung des Kursbeitrages gültig.
Bankverbindung: Raiffeisenkassa
Bozen: IBAN:
IT 68 V 08081 11600 000300031208

Gesundes und behagliches Wohnen bedeutet Lebensqualität, die wir uns großteils selbst gestalten können. Es gilt dabei, auf einige Details zu achten und uns mit unserer Wohn-Umgebung auseinanderzusetzen.
Gesundes und behagliches Wohnen bedeutet Lebensqualität, die wir uns großteils selbst gestalten können. Es gilt dabei, auf einige Details zu achten und uns mit unserer Wohn-Umgebung auseinanderzusetzen.

Bei den verschiedenen Substanzen, welche sich in der Raumluft befinden können, hängt es nicht nur von der Dosis und der jeweiligen Wirkung ab, sondern jeder Mensch reagiert auch anders auf die unterschiedlichen Stoffe. Bei älteren Menschen, aber auch bei Babys und gesundheitlich bereits angeschlagenen Personen ist das Risiko einer zusätzlichen Erkrankung oder einer Verstärkung von Symptomen viel höher.
Wussten Sie, dass die Luft in geschlossenen Räumen bis zu fünfmal mehr Schadstoffe enthalten kann als die Luft im Freien?
Welche Faktoren für ein gesundes Wohnumfeld verantwortlich sind, wo sich die Quellen für Wohngifte verstecken und was jeder und jede Einzelne zur eigenen Wohngesundheit beitragen kann, darüber informiert der neue Südtiroler Online-Ratgeber „Gesundes und nachhaltiges Wohnen“. Ein Gemeinschaftswerk des Bildungs- und Energieforum AFB in Zusammenarbeit mit der Verbraucherzentrale Südtirol und finanzieller Unterstützung des Raiffeisenverbandes Südtirol.








Onlineratgeber „Gesundes nachhaltiges Wohnen“

Kinder sind das schönste Geschenk. Damit Sie sich auf das wirklich Wichtige im Leben konzentrieren können, schenken wir Ihnen einen Bonus von 300 Euro in der Stromrechnung. Gültig für alle unsere Haushaltskunden in Südtirol mit steuerlich zu Lasten lebenden Kindern bis 24 Jahre.

Fragen Sie
online Ihren Alperia



Familienbonus an!
Alle Details unter alperia.eu/familienbonus

Jedes Stück ein Unikat, angepasst an Ihre persönlichen Anforderungen. Die neuen Hörsysteme sind nahezu unsichtbar und bieten hohen Hörkomfort und besten Klang.

Bozen
Romstraße 18M
Mo.-Fr. 8.30-12.30 Uhr
14.30-18.30 Uhr
Brixen
Stadelgasse 15A
Mo.-Fr. 8.30-12.30 Uhr
14.00-18.00 Uhr
Bruneck
Herzog-Sigmund-Straße 6C
Mo.-Fr. 8.30-12.30 Uhr
14.00-18.00 Uhr
Meran
Freiheitsstraße 99
Mo.-Fr. 8.30-12.30 Uhr
14.00-18.00 Uhr
Neumarkt
Optik Julius Rathausring 36
jeden Mittwoch
8.30-12.00 Uhr
Prad
Apotheke Prad
Kreuzweg 2A
jeden 1. Dienstag im Monat
8.30-12.30 Uhr
Schlanders
Ex-Ambulatorium Dr. Tappeiner Karl-Schönherr-Straße 19
jeden Donnerstag
8.30-12.30